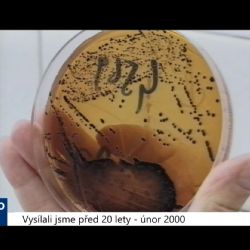
2000 – Mariánské Lázně: Největší epidemie salmonelózy v republice (TV Západ)

Archiv zpráv - únor 2020
- 02.03.2020
Karlovarský kraj: Zprávy 10. týdne 2020 (TV Západ)
Vysílání 02.03.2020-06.03.2020, 1. Cheb: Kamerový systém se má rozšířit a zmodernizovat (TV Západ), 2. Sokolov: Další šatny na zimním stadionu jdou do oprav (TV Západ), 3. Karlovarsko: Angličtinu s americkým vojákem vyzkouší 16 škol (TV Západ), 4. Bochov: Maškarní ovládly Mimina a Kadibudka (TV Západ), 5. Žlutice: Lesnická škola opraví další prostory (TV Kraj)
Celý článek- 02.03.2020
SZPI stále odhaluje v potravinách vyšší obsah alergenů než je uvedeno na obalu
Státní zemědělská a potravinářská inspekce (SZPI) nařídila neprodlené stažení z tržní sítě níže uvedených nevyhovujících potravin pro překročení obsahu alergenních látek oproti informaci na obalu o několik řádů.
Celý článek- 02.03.2020
Pes pro Kačku
Sbírková akce na detekčního psa pro Kačku s Diabetem Mellitus - osmileté Kateřině Ele Kondelčíkové z Karlovarska se v březnu 2017 změnil život. Po zachycení prvních příznaků ji bylo diagnostikováno nevyléčitelné onemocnění Diabetes Mellitus 1. typu. Toto onemocnění velice ovlivňuje pacientův život a pacient je tak odkázán na pravidelné podávání inzulinu.
Celý článek- 02.03.2020
Karlovy Vary: Očekávejte omezení provozu v ul. Poděbradská a Divadelní náměstí
Od 3.3.2020 do 4.3.2020 bude částečně omezen provoz na Divadelním náměstí. Důvodem omezení je umístění filmové techniky a stanu z důvodu natáčení „Superstar“ v Karlovarském městském divadle.
Celý článek- 02.03.2020
Sokolovsko: Policie objasnila série vloupání do garáží
Sokolovští kriminalisté sdělili podezření ze spáchání přečinů krádeže, poškození cizí věci a porušování domovní svobody šestatřicetiletému muži z Chodova.
Celý článek- 02.03.2020
Karlovy Vary, Cheb: Nemocnice ruší zákaz návštěv
Karlovarská krajská nemocnice s okamžitou platností ruší, po dohodě s hygieniky, zákaz návštěv na lůžkových odděleních nemocnic v Karlových Varech a Chebu.
Celý článek- 02.03.2020
Aš: Přepadl nezletilého. Chlapci pomohl kolemjdoucí
Chebští kriminalisté zahájili trestní stíhání místního třicetiletého muže, kterého obvinili ze spáchání zvlášť závažného zločinu loupeže.
Celý článek- 02.03.2020
2010 – Cheb: Velké opravy Riegrovy ulice začnou v březnu (3978) (TV Západ)
Celková oprava chebské Riegrovy ulice odstartuje přesně 1. března. Hotovo by mělo být již za čtyři měsíce. Jedná se o další, v pořadí třetí etapu rekonstrukčních prací v této části města. Loni byly dokončeny úpravy Palackého ulice a vnitrobloku Nová, Krátká.
Celý článek- 02.03.2020
Sokolov: Kam se vydat na houby?
S unikátní novinkou, kterou jistě ocení především houbaři, přichází město a společnost SOTES. V parcích budou „vysazeny“ houby, které budou na podzim připraveny ke sběru. Půjde o populární a chutné druhy - hlívu ústřičnou a hlívu citronovou. Sokolov je první město v regionu, které bude pěstovat houby pro veřejnost. Využije přitom staré pařezy.
Celý článek- 02.03.2020
Komunitní centrum Chebsko zahajuje kampaň Daruj krev - Zachraň život
Cílem akce je mladým lidem a především studentům přiblížit dárcovství krve jako běžnou součást života a upozornit je, že se sami mohou dostat do situace, kdy darovanou krev budou potřebovat.
Celý článek- 02.03.2020
Chebsko: Ponechal si peníze za doručenou zásilku
Policisté z Obvodního oddělení Mariánské Lázně sdělili podezření ze spáchání přečinu podvodu čtyřiadvacetiletému muži ze Sokolovska.
Celý článek- 01.03.2020
Františkovy Lázně: U města došlo k dopravní nehodě
Na silnici 21 u Františkových Lázní, okres Cheb, došlo k dopravní nehodě bez zranění - střet dvou vozidel. Na místě PČR.
Celý článek- 01.03.2020
2000 – Františkovy Lázně: S nožem v ruce vyhrožoval majitelce bytu (TV Západ)
Horké chvíle prožila kvůli podkrovnímu bytu ve svém činžovním domě 69letá žena z Františkových Lázní. Majitelka domu se přednedávnem obrátila na soud, jež rozhodl, že jeden z nájemníků, který svůj byt nevyužíval, a naopak ho celý zdemoloval, ho musí vyklidit. Ten se po obdržení soudního rozhodnutí vydal za majitelkou domu.
Celý článek- 01.03.2020
Každá šestá restaurace připravuje pokrmy na přepáleném oleji
V rámci pravidelné kontrolní akce Státní zemědělská a potravinářská inspekce (SZPI) prověřila jakost a bezpečnost fritovacích olejů, které provozovatelé restaurací a rychlých občerstvení používají k přípravě pokrmů. V každé šesté kontrolované provozovně inspektoři SZPI vyhodnotili olej ve fritovacích zařízeních za nevhodný k lidské spotřebě.
Celý článek- 01.03.2020
Tradiční výrobek roku 2020
Do soutěže Tradiční výrobek roku se může přihlásit nebo být nominován každý, kdo vyrábí něco zajímavého – podmínkou není, že musí podnikat. Musí být však ze zájmového území - z Karlovarského kraje.
Celý článek- 01.03.2020
Region: Počet nemocných respirační infekcí klesá
Nemocnost akutních respiračních infekcí (dále jen „ARI“) v Karlovarském kraji vychází z týdenních hlášení praktických lékařů pro dospělé a praktických lékařů pro děti a dorost. Jedná se o vážená a standardizovaná data s využitím počtu obyvatel v jednotlivých okresech a jednotlivých věkových skupinách.
Celý článek- 01.03.2020
Děpoltovice: Osobní vozidlo narazilo do svodidel
Na silnici 2192 u obce Děpoltovice, okres Karlovy Vary, došlo k dopravní nehodě bez zranění - osobní vozidlo zde narazilo do svodidel. Na místě PČR. Pozor! Komunikace je neprůjezdná.
Celý článek- 01.03.2020
Karlovy Vary: Mladík kradl vše, co mu přišlo pod ruku
Policisté z Obvodního oddělení Karlovy Vary – město sdělili 19letému muži z Karlovarska podezření ze spáchání přečinu krádež.
Celý článek- 01.03.2020
Mariánské Lázně: Při likvidaci požáru domu se zranil jeden hasič
Bytový dům vyhořel v noci z pátku na sobotu v Mariánských Lázních. Hořet začalo v podkroví a oheň zasáhl všech šest bytů a také střechu domu. Hlášení o požáru přijali hasiči na tísňovou linku krátce po třetí hodině ráno. Když na místo dorazila první jednotka ze stanice Mariánské Lázně, hořela již celá střecha pětipatrového domu.
Celý článek- 01.03.2020
2000 – Bad Brambach: Výroční konference Euregia Egrensis (TV Západ)
V sousedním saském Bad Brambachu se uskutečnila výroční tisková konference Euregia Egrensis, které je sdružením měst a obcí na české a německé straně hranice. Při hodnocení činnosti Euregia zazněla z úst za českou část kritika centrálních orgánů České republiky. Konkrétně vlády a parlamentu, které význam těchto přeshraničních subjektů podceňují, což je alarmující především vzhledem k procesu přidružování republiky k Evropské unii.
Celý článek- 29.02.2020
2000 – Cheb: Úřednice MP zpronevěřila přes 200 tisíc (TV Západ)
Obvinění z trestného činu zpronevěry čelí 35letá administrativní pracovnice chebského Městského úřadu, která pracovala konkrétně u Městské policie. Tato úřednice vybírala poplatky za dlouhodobé parkovací karty a za povolení vjezdu do pěší zóny. Policistům se podařilo zjistit, že tyto poplatky ve více než 560 případech nezaúčtovala.
Celý článek- 29.02.2020
Karlovy Vary: Nové jízdní řády MHD doznají změn
Nové jízdní řády karlovarské městské hromadné dopravy doznají dílčích změn. Vedení města požádalo Dopravní podnik Karlovy Vary o zapracování nejčastějších požadavků cestujících.
Celý článek- 29.02.2020
Region: Chodci, dbejte na své zviditelnění!
Dne 27. února 2020 na území Karlovarského kraje proběhla dopravně bezpečnostní akce zaměřená na dodržování pravidel silničního provozu ze strany chodců, a to zejména na řádné přecházení přechodů a na povinnost mít na sobě ve vymezených případech reflexní prvky. Dále se také policisté zaměřili na kontrolu řidičů motorových vozidel a také jejich povinnosti ve vztahu k chodcům přecházejícím pozemní komunikace.
Celý článek- 29.02.2020
Karlovy Vary: Pozor! U města došlo k dopravní nehodě
Na silnici 6 u Karlových Varů došlo k dopravní nehodě osobního vozidla. To je napříč přes silnici - nebezpečná situace!
Celý článek- 29.02.2020
Mariánské Lázně: Hasiči museli z hořícího hotelu evakuovat 9 osob
Dnes došlo v Mariánských Lázních, v hotelu Britania k požáru podkrovní části a střechy. Bylo evakuováno 9 osob a vyhlášen 3. stupeň poplachu. Událost byla naštěstí bez zranění ubytovaných.
Celý článek- 29.02.2020
Cheb: Osobní vozidlo narazilo do stromů
V Chebu, v ulici K Nemocnici došlo k dopravní nehodě bez zranění - osobní vozidlo zde narazilo do stromů. Na místě HZS a PČR.
Celý článek- 29.02.2020
Karlovy Vary: Převozů na PZS bylo loni méně
Převozy osob pod vlivem alkoholu, které nekontrolují své chování a stávají se tak nebezpečnými nejen pro své okolí, ale mnohdy i sebe, již několik let dopravují do sokolovské protialkoholní záchytné stanice městští strážníci. Ti v roce 2019 zaevidovali dvě změny oproti předešlým létům.
Celý článek- 29.02.2020
2000 – Cheb: Stavba Průmyslového parku se odkládá (TV Západ)
Chebská radnice letos nezahájí stavbu Průmyslového parku. Hlavním důvodem má být současná nepřipravenost města projekt realizovat. Objekt měl stát na pozemcích sousedících s obchvatem Chebu. Radnice dosud nezajistila změnu územního rozhodnutí. Navíc se nepodařilo tyto pozemky včas vykoupit od soukromých majitelů. Tím zřejmě padla možnost finanční podpory od Evropské unie v hodnotě 2 milionů euro, což je v přepočtu přibližně 70 milionů korun.
Celý článek- 28.02.2020
Kojšovice: U obce havarovalo osobní vozidlo do příkopu
Na silnici 198 u obce Kojšovice došlo k dopravní nehodě bez zranění - osobní vozidlo zde havarovalo do příkopu. Na místě PČR.
Celý článek- 28.02.2020
Karlovarský kraj: Archivní zprávy 09. týdne 2020 (TV Západ)
Vysílání 28.02.2020-02.03.2020, 1. 2000 – Cheb: Stavba Průmyslového parku se odkládá (TV Západ), 2. 2000 – Cheb: Úřednice MP zpronevěřila přes 200 tisíc (TV Západ), 3. 2000 – Bad Brambach: Výroční konference Euregia Egrensis (TV Západ), 4. 2000 – Františkovy Lázně: S nožem v ruce vyhrožoval majitelce bytu (TV Západ), 5. 2010 – Cheb: Velké opravy Riegrovy ulice začnou v březnu (3978) (TV Západ)
Celý článek- 28.02.2020
Sokolov: Hokejový zápas pro Standu
Hokejový život přináší hráčům různé soupeře. Někdy hokejisté narazí na protivníky z kategorie lehčích, někdy se musí poměřit se silným sokem. Jsou bohužel i chvíle, kdy se někteří hráči musí popasovat se soupeřem z kategorie nejtěžších. Tak, jako v případě hráče 4. třídy, Stanislava France, který v současné době bojuje s „drakem."
Celý článek- 28.02.2020
Region: Celníci zajistili 20 nelegálních hracích automatů
Karlovarští celníci od začátku letošního roku zajistili ve třech hernách 20 nelegálních hracích automatů v celkové hodnotě 2 miliony korun a finanční hotovost bezmála 35 tisíc korun. Celníci se opět zaměřili na dodržování zákona o hazardních hrách a od ledna provedli v karlovarském regionu 14 kontrol, z nichž 8 bylo pozitivních.
Celý článek- 28.02.2020
Seznamte se s pestrým životem rudných dolů
Nenechte si ujít zajímavou přednášku, která se uskuteční již tuto sobotu 29. února v prostorách Královské mincovny Jáchymov. Lukáš Falteisek z katedry ekologie Univerzity Karlovy v Praze a člen České speleologické společnosti promluví o ekosystému rudných dolů, jenž je dokonce bohatší než živá příroda v jiných typech podzemí.
Celý článek- 28.02.2020
Krušné hory dnes začínají hostit juniorské mistrovství světa
Na 43. juniorském mistrovství světa v klasickém lyžování v Oberwiesenthalu se od 28. února do 8. března sejde světová špička mladých závodníků. Šampionát bude zahrnovat soutěže v klasických disciplínách, jako jsou skoky na lyžích, běh na lyžích a severská kombinace. O napínavou podívanou tedy rozhodně nebude nouze.
Celý článek- 28.02.2020
Nový Kostel: Nalezenou munici zajistil a odvezl pyrotechnik
Policisté z Obvodního oddělení Plesná vyjeli ve čtvrtek 27. 2. 2020 kolem 15. hodiny do lesního porostu mezi Novým Kostelem a Kopaninou k případu nálezu munice. Tu našel muž při procházce a následně to oznámil na tísňovou linku 158. Po příjezdu na místo se hlídka spojila s oznamovatelem, který jim nalezenou munici ukázal.
Celý článek- 28.02.2020
Toužim: Osobní vozidlo narazilo do dopravního značení
Na silnici 20 u Toužimi, okres Karlovy Vary, došlo k dopravní nehodě - osobní vozidlo zde narazilo do dopravního značení. Průjezd je možný se zvýšenou opatrností. Překážka na vozovce. Na místě PČR.
Celý článek- 28.02.2020
Mnichov: Dnešní ranní nehoda nákladního vozidla
Na silnici z Mariánských Lázní směrem na Bečov - u obce Mnichov havarovalo před osmou hodinou ráno jedno nákladní auto, které se převrátilo na bok. Řidič byl naštěstí bez zranění a provoz v místě nehody průjezdný. Komplikace je možné očekávat v průběhu dne při vyprošťování auta zpět na silnici.
Celý článek- 28.02.2020
Ostrov: Policie pátrá po svědcích dopravní nehody
Dopravní policisté z Karlových Varů pátrají po svědcích dopravní nehody, ke které došlo dne 25. února 2020 v čase od 13:15 do 13:50 hodin na ulici Jáchymovská v Ostrově před obchodním domem Kaufland.
Celý článek- 28.02.2020
Březová: Nejlepší sportovci roku 2019 převzali ocenění (TV Západ)
Slavnostní předání cen Sportovcům roku 2019 se uskutečnilo v úterý 18. února v kinosále Kulturního domu v Březové na Sokolovsku. Mezi gratulanty se objevilo několik významných sportovních jmen. Jejich představování se neslo v hravém duchu, podobně jako celý večer.
Celý článek- 28.02.2020
Žluticko: Napřed 81leté seniorce pomáhala, poté ji okradla
Policisté z Obvodního oddělení Žlutice sdělili 28leté ženě ze Žluticka podezření ze spáchání přečinu krádež. Takového jednání se měla dopustit v období od listopadu do prosince roku 2019.
Celý článek- 28.02.2020
Karlovarsko: Trestnou činnost páchá jak na běžícím páse
Oznámení z půl šesté ráno včerejšího dne prověřili strážníci s pozitivním výsledkem. Časté krádeže katalyzátorů, lokalita Stará Role a zvuk brusky vycházející zpod vozidla, dávaly tušit, že si strážníci připíší na konto dalšího pachatele trestné činnosti.
Celý článek- 28.02.2020
Region: Odcizil dva přívěsy
Dne 4. února 2020 čtyřiatřicetiletý muž ze Sokolovska nahlásil krádež nákladního přívěsu, který měl připojen na tažném zařízení u svého zaparkovaného vozidla tovární značky Honda. Po oznámení policisté začali po pachateli a přívěsu intenzivně pátrat. Po pár dnech si policista v civilu z Obvodního oddělení Bečov nad Teplou během své cesty domů všiml projíždějícího automobilu Volkswagen s přívěsem, o kterém se domníval, že by mohl odpovídat popisu odcizeného přívěsu z Krásna.
Celý článek- 27.02.2020
Kynšperk: Město poděkovalo dárcům krve a zdravotníkům (TV Západ)
V pondělí 17. února se na kynšperské radnici konalo přijetí dárců krve a oceněných zdravotníků. Město tímto chtělo vyjádřit poděkování svým občanům.
Celý článek- 27.02.2020
Soutěž EY Podnikatel roku 2019 zná již svého vítěze
Společnost Ernst & Young ve spolupráci s Karlovarským krajem vyhlásila vítěze mezinárodní soutěže EY Podnikatel roku 2019 Karlovarského kraje. Jako nejlepšího zde nezávislá porota ocenila Alessandra Pasquale, ředitele společnosti Mattoni 1873 a.s. Jde o největšího středoevropského výrobce nealkoholických nápojů, jenž zaměstnává v osmi zemích přes tři tisíce lidí
Celý článek- 27.02.2020
Sokolov: Tylovku čekají velké stavební úpravy
Stavební úpravy jsou naplánovány v ulici J. K. Tyla v centrální části města Sokolov. Rekonstrukce čeká nejen komunikaci, ale také to, co se ukrývá pod ní. Tedy vodovod a kanalizaci. Stavba je rozdělena na dvě etapy. První v rozsahu od Lobezského potoka po křížení ulice J. K. Tyla s ulicí Maxima Gorkého začne 4. března a potrvá do konce června.
Celý článek- 27.02.2020
Cheb: Rok 2020 v duchu Valdštejnů
Včera došlo k zahájení valdštejnského roku uctěním památky Albrechta z Valdštejna před chebským muzeem.
Celý článek- 27.02.2020
Kontrola chatových oblastí a zahrádek na Sokolovsku
V teritoriu Obvodního oddělení Kraslice proběhla ve čtvrtek 20. února 2020 policejní akce „Zabezpečte se! Chraňte majetek sobě a svým sousedům,“ a to v rámci plnění celorepublikového projektu. Akce proběhla v součinnosti odborem služby pořádkové policie, oddělením služební kynologie a skupinou základních kynologických činností.
Celý článek- 27.02.2020
V obci Krásný Les uvízlo nákladní vozidlo
V obci Krásný Les, okres Karlovy Vary, uvízlo nákladní vozidlo. Překážka na vozovce - průjezd je možný se zvýšenou opatrností.
Celý článek- 27.02.2020
Region: Od čerpacích stanic odjížděl bez placení
Čtyřiapadesátiletý muž z Karlových Varů měl od začátku ledna do začátku února letošního roku ujíždět od čerpacích stanic bez zaplacení. A to nejen v Karlovarském kraji. Za pohonné hmoty totiž neplatil ani v kraji Plzeňském.
Celý článek- 27.02.2020
Vojtanov: Pozor! Nehoda se zraněním
Na silnici 213 u Vojtanova došlo k dopravní nehodě se zraněním - havarovalo zde osobní vozidlo. Na místě ZZS a PČR.
Celý článek- 27.02.2020
Meteorologové varují před silným sněžením doprovázeným větrem
Výstraha platí i pro Karlovarský kraj, a to ode dneška, 27. února 19 hodin, do zítřejšího rána. Sníh by mohl zkomplikovat dopravu, působit škody na stromech a výpadky v energetice. Nezapomeňte na zimní výbavu, při cestách do hor i na sněhové řetězy.
Celý článek- 27.02.2020
Hájek: Posilněn alkoholem řídil cizí vozidlo
V sobotu dne 22. února 2020 kolem půl desáté večerní v obci Hájek policisté z Obvodního oddělení Ostrov předepsaným způsobem zastavili osobní vozidlo značky Škoda s dvěma pasažéry. Řidiče následně vyzvali k předložení předepsaných dokladů pro provoz a řízení motorových vozidel a podrobení se orientační dechové zkoušky.
Celý článek- 27.02.2020
2010 – Cheb: Masopust trpaslíků – Bez komentáře (TV Západ)
V Chebu se uskutečnil v sobotu 6. února tradiční masopustní průvod. Tentokrát byli hlavním tématem trpaslíci ve všech formách.
Celý článek- 27.02.2020
Kynšperk: Domy poškozené důlní vodou opraví stát
V Kynšperku nad Ohří se konečně řeší domy, které poškodila důlní voda. Celkem jde o 21 objektů s různou mírou vlhkosti na různém podloží, proto se k nim bude přistupovat individuálně. Tak, aby vše bylo vyřešeno do konce příštího roku. Lidem, kteří v domech bydlí, to osobně řekl vicepremiér a ministr průmyslu, obchodu a dopravy Karel Havlíček. A to na setkání v kynšperském kině, kterého se zúčastnilo několik desítek obyvatel.
Celý článek- 27.02.2020
Odeř: Střet dvou vozidel
Dne 25.2.2020 vyjížděli Hasiči Ostrov k dopravní nehodě se zraněním - střet dvou vozidel, která se stala u obce Odeř.
Celý článek- 27.02.2020
Karlovy Vary: Při krádeži byl přistižen policisty
Krást se měl pokusit v polovině února 57letý muž z Karlovarska. V pozdních nočních hodinách měl za užití násilí pomocí přinesených nástrojů se pokoušet vniknout do technické místnosti panelového domu.
Celý článek- 26.02.2020
Sokolov: Při úpravách chemičáku dojde i k oplocení hrobky (TV Západ)
Oplotit opravenou hrobku rodiny Schusterových se chystá město Sokolov. Advokát Franz Schuster byl městským právníkem v Falknově, jedním ze šesti tehdy působících právníků. V bezprostřední blízkosti přitom právě probíhá druhá fáze úprav svahu pod rozhlednou Hard.
Celý článek- 26.02.2020
Bezpečnostní rada kraje zasedne v souvislosti se šířením koronaviru
Vzhledem k rostoucímu počtu nakažených lidí koronavirem v okolních evropských státech svolá hejtman Karlovarského kraje Petr Kubis jednání Bezpečnostní rady Karlovarského kraje. Zasedání se uskuteční v pondělí 2. března. Hejtman to potvrdil po dohodě s ředitelem Hasičského záchranného sboru Karlovarského kraje Václavem Klemákem. Kromě toho kraj také nechá vyrobit další respirátory pro krajské nemocnice a policii.
Celý článek- 26.02.2020
Sokolov: Generál Petr Pavel zavítá do města
Armádní generál Petr Pavel a bývalý velvyslanec Petr Kolář navštíví v úterý 3. března 2020 město Sokolov. Na Sokolovsko zavítají na pozvání senátora Miroslava Balatky. Ten jim chce představit region a zároveň zprostředkovat setkání s místními lidmi.
Celý článek- 26.02.2020
Na začátku března se rozeběhnou práce na nové lávce ve Svatoškách
Chystáte se na předjarní výlet do okolí Svatošských skal? Tak dejte pozor, protože od začátku března začnou práce na stavbě nové lávky přes řeku Ohři. Na cyklostezce směrem od Lokte můžete od prvních březnových dnů potkat stavební techniku a stroje.
Celý článek- 26.02.2020
Cheb: Hasiči zachránili bobra
Hasiči JSDH Cheb zachránili bobra uvízlého v dopravního nad česly hráze Skalka. Bobr byl odchycen a vypuštěn zpátky do přírody.
Celý článek- 26.02.2020
Cheb: Omezený provoz v Dlouhé ulici
V ulici Dlouhá probíhá výšková úprava kamenných obrub v souvislosti s opravou povrchu chodníku. Během dnešního dne bude provoz v Dlouhé ulici omezen. Pro obyvatele ulice Provaznická a přilehlého úseku ulice Dlouhá je přístup k nemovitostem umožněn.
Celý článek- 26.02.2020
Nejdek: Osobě, která vypadla z balkónu, již nebylo možno pomoci
Hasiči Nejdek dnes v dopoledních hodinách vyjížděli do ulice Dvořákova, Nejdek, k záchraně osoby, která vypadla z balkónu v 1 patře. Jednotka na místě spolupracovala se ZZS při resuscitaci. Přes veškerou snahu záchranářů osoba svým zraněním na místě podlehla.
Celý článek- 26.02.2020
BBC natáčela v Jáchymově
Jáchymov, malé město na západě Čech, bylo klíčové v oblasti výzkumu radioaktivity. Před více než sto lety založili Marie a Pierre Curie své revoluční práce o radioaktivním materiálu na základě výzkumu právě v Jáchymově.
Celý článek- 26.02.2020
Sokolovsko: Odcizené nářadí si odvezl odcizeným vozidlem
Sokolovští kriminalisté sdělili podezření ze spáchání přečinů krádeže, neoprávněného užívání cizí věci a maření výkonu úředního rozhodnutí a vykázání šestačtyřicetiletému muži z Kraslic.
Celý článek- 26.02.2020
2010 – Cheb: Výběrové řízení na provozovatele kamerového systému (3974) (TV Západ)
Město Cheb chce vyhlásit výběrové řízení na provozovatele kamerového systému. Tomu současnému v dubnu končí smlouva.
Celý článek- 26.02.2020
Cheb: Brzy začne rekonstrukce Zemědělské ulice
V jarních měsících, pravděpodobně v průběhu května, bude zahájena dlouho připravovaná celková rekonstrukce Zemědělské ulice v Hájích. Na základě výsledku nedávného výběrové řízení na dodavatele bude stát přibližně 32,7 milionu korun, což je o 3 miliony méně, než kolik činil odhad nákladů v projektové dokumentaci.
Celý článek- 26.02.2020
Karlovy Vary: V Krajské knihovně bude Den zdravého mozku (TV Západ)
Den zdravého mozku se po roce opět uskuteční v Karlových Varech. A to 19. března v Krajské knihovně. Hlavním tématem je vliv moderních technologií. Akce bude mít odbornou část a laickou, na kterou je zvána široká veřejnost, především rodiče.
Celý článek- 26.02.2020
Cheb: Oloupili 18letou dívku
Chebští kriminalisté zahájili trestní stíhání devětadvacetiletého muže ze Sokolovska a čtyřiatřicetileté ženy z Chebska, které obvinili ze spáchání zvlášť závažného zločinu loupeže. Muž byl navíc obviněn ze spáchání přečinu neoprávněného opatření, padělání a pozměnění platebního prostředku.
Celý článek- 25.02.2020
Cheb: Střet dvou vozidel
V Chebu, v ulici nám. Prokopa Holého došlo k dopravní nehodě bez zranění - střet dvou vozidel. Na místě PČR. S opatrností průjezdné.
Celý článek- 25.02.2020
Cheb: Na opravy střechy DPS Mírová naváže zateplení budovy (TV Západ)
Domov pro seniory v Chebu v Mírové ulici se dočká havarijní opravy střechy. To urychlilo i plánované zateplení budovy a další dovybavení.
Celý článek- 25.02.2020
Region: Kradli vše, co jim přišlo pod ruku, dokonce i trpaslíka
Čtyřiatřicetiletý muž z Kynšperku nad Ohří měl na konci minulého roku po domluvě zpracovávat dřevo na pozemku devětašedesátileté ženy. V nestřeženém okamžiku měl vstoupit do zahradní kůlny, kterou měl prohledat. Nakonec z ní měl odcizit elektrickou řetězovou pilu a tím způsobit škodu dva tisíce korun.
Celý článek- 25.02.2020
Vloni se v Chebu rekordně třídilo
V Chebu se vloni vytřídilo rekordní množství odpadu. Konkrétně se jednalo o 624 tun papíru, 415 tun plastů, 336 tun skla a 3460 tun bioodpadu. Nárůst činil u těchto čtyř komodit v porovnání s rokem 2018 celkově 884 tun, tedy přes 22 %. V průběhu loňského roku se v Chebu navíc začaly nově separovat také kovové obaly. V kontejnerech jich skončily 2 tuny.
Celý článek- 25.02.2020
Chodov: Město podpořilo obnovu trati do Krásného Jezu
Uzavřenou železniční trať Krásný Jez – Chodov by rádi vrátili do života chodovští zastupitelé. Ti její obnovu a zprovoznění na svém únorovém jednání jednoznačně podpořili.
Celý článek- 25.02.2020
Chystáte rodinnou nebo firemní akci? Rádi vám připravíme catering na míru!
Do chutí a vůní našich jídel se zamilujete!
Celý článek- 25.02.2020
Aš: Havárie vodovodu uzavře Pivovarskou ulici
Společnost CHEVAK Cheb a.s. bude zítra, tedy 26. 2. 2020, opravovat havárii vodovodu v ul. Pivovarská (k poruše došlo u schodů k bývalé restauraci U Tří lipanů). Komunikace v uvedené ulici bude po dobu opravy uzavřena. Předpokládá se, že oprava potrvá jeden den.
Celý článek- 25.02.2020
Pozor! Aktuálně jsou v našem kraji tři nehody
- na silnici 198 u Teplé, okres Cheb, zde havaroval obytný vůz, hrozí jeho převrácení. Na místě PČR a HZS
Celý článek- 25.02.2020
2010 – Sokolov: Město chce zateplit další školské objekty (3948) (TV Západ)
Po loňském úspěchu v zateplování školských objektů hodlá i letos sokolovská radnice pokračovat. Sedm zařízení vloni získalo na investicích 120 milionů korun. Dotace ze Státního fondu životního prostředí činila přes dvě třetiny celkového objemu. Pro letošek se plánují k zateplení čtyři školky a další objekty ve správě města.
Celý článek- 25.02.2020
Cheb: Střet dvou vozidel
V Chebu, v ulici Wolkerova, křižovatka s ul. Karlova, došlo k dopravní nehodě bez zranění - střet dvou vozidel. Na místě PČR.
Celý článek- 25.02.2020
Dalovice: Pod vlivem alkoholu ujížděl policistům
V sobotu dne 22. února 2020 ve večerních hodinách policisté z dopravního inspektorátu Karlovy Vary prováděli na ulici Hlavní v Dalovicích dohled nad bezpečností a plynulostí silničního provozu.
Celý článek- 25.02.2020
Cheb: Plameny v noci zničily část tržnice u města
Ostraha areálu tržnice Svatý Kříž u Chebu zpozorovala požár v jednom prodejním stánku krátce před jednou hodinou v noci z pondělí na úterý. Ihned po oznámení na tísňovou linku hasičů vyjeli k požáru jednotky z prvního stupně poplachového plánu.
Celý článek- 25.02.2020
Karlovy Vary: Městský kamerový systém odhalil případ nakládání s vraky
Městský kamerový dohledový systém dal impuls k zajímavému případu nakládání s vraky. V sobotu 8. února strážník z operačního střediska zjistil přes kameru umístěnou u garáží v Jabloňové ulici větší množství autovraků.
Celý článek- 25.02.2020
Sokolovsko: Odcizili přes 100 metrů kabelů
Pětadvacetiletý muž společně se svým teprve devatenáctiletým kamarádem měli na začátku února letošního roku vyrazit v nočních hodinách do dolového území na Sokolovsku.
Celý článek- 25.02.2020
Karlovy Vary: Nalezenou platební kartu používal jako vlastní
Karlovarští kriminalisté zahájili trestní stíhání třicetiletého muže z Karlových Varů, kterého obvinili ze spáchání přečinu neoprávněné opatření, padělání a pozměnění platebního prostředku.
Celý článek- 24.02.2020
Karlovarský kraj: Zprávy 09. týdne 2020 (TV Západ)
Vysílání 24.02.2020-28.02.2020, 1. Cheb: Na opravy střechy DPS Mírová naváže zateplení budovy (TV Západ), 2. Karlovy Vary: V Krajské knihovně bude Den zdravého mozku (TV Západ), 3. Sokolov: Při úpravách chemičáku dojde i k oplocení hrobky (TV Západ), 4. Cheb: Kamerový systém se má rozšířit a zmodernizovat (TV Západ), 5. Kynšperk: Město poděkovalo dárcům krve a zdravotníkům (TV Západ),
Celý článek- 24.02.2020
Autorem nového loga Institutu lázeňství a balneologie je student keramky
?Institut lázeňství a balneologie, v.v.i., který v loňském roce zřídil Karlovarský kraj, má zbrusu nové logo. V soutěži o jeho podobu zvítězil Karel Antonín Kalvas, student třetího ročníku oboru grafický design Střední uměleckoprůmyslové školy keramické a sklářské v Karlových Varech. Logo ztvárňuje stylizovanou baňku, jež v sobě ukrývá třetí rozměr.
Celý článek- 24.02.2020
Stezka mezi Sokolovem a Dolním Rychnovem je hotová
Chodci i cyklisté už mohou oficiálně využívat novou víceúčelovou stezku, které byla dokončena mezi Sokolovem a Dolním Rychnovem. Její stavba začala loni na jaře a letos v závěru února byla stavební firmou předána městu, které bylo investorem této akce.
Celý článek- 24.02.2020
Královské Poříčí: Na Statku Bernard spojí Masopust s Oslavou jídla
V sobotu 7. 3. 2020 od 11 do 15 hodin se na Statku Bernard v Královském Poříčí uskuteční Masopust - Oslavy jídla. Přijďte se bavit a hodovat na Statek Bernard!
Celý článek- 24.02.2020
Blíží se uzávěrka výtvarné soutěže pro seniory
Už jen několik málo dní mají senioři na to, aby se zúčastnili oblíbené výtvarné soutěže s názvem „Věk pro nás není překážkou.“ Soutěž je určena pro všechny obyvatele Karlovarského kraje, kteří jsou starší šedesáti let a věnují se některé z výtvarných činností.
Celý článek- 24.02.2020
Region: Počet nemocných respirační infekcí a chřipkou opět roste
Nemocnost akutních respiračních infekcí (dále jen „ARI“) v Karlovarském kraji vychází z týdenních hlášení praktických lékařů pro dospělé a praktických lékařů pro děti a dorost. Jedná se o vážená a standardizovaná data s využitím počtu obyvatel v jednotlivých okresech a jednotlivých věkových skupinách.
Celý článek- 24.02.2020
Karlovy Vary: Střet tří vozidel
Na silnici 6 u Karlových Varů došlo k dopravní nehodě - střet tří vozidel. Místo je s opatrností průjezdné.
Celý článek- 24.02.2020
Region: Hasiči vyjížděli k téměř 80 událostem spojených s větrem
Odstranění spadlých stromů na silnice nebo na dráty elektrického či telefonního vedení. To byl nejčastější důvod výjezdů hasičů od nedělního odpoledne do pondělního rána. Kvůli silnému větru vyjížděli hasiči v 78 případech, zásah provedli celkem na 92 místech.
Celý článek- 24.02.2020
Cheb: Opilá řidička narazila do nočního klubu
V neděli 23. února došlo v nočních hodinách v Chebu v ulici Truhlářská k dopravní nehodě. K té mělo dojít tak, že sedmadvacetiletá řidička jela v osobním vozidle značky Mercedes ve směru jízdy od ulice Pražská směrem k ulici Pekařská.
Celý článek- 24.02.2020
2010 – Cheb: Cena za odpad zůstává pro občany stejná (3968) (TV Západ)
Jako každý rok i letos vyšla v Chebu nová obecně závazná vyhláška o odpadech. Stanovuje ceny za likvidaci. Zásadní informací pro obyvatele je fakt, že nebudou platit více než loni.
Celý článek- 24.02.2020
Karlovy Vary: Ponechala si peníze za zprostředkování koupě bytu
Kriminalisté z oddělení hospodářské kriminality v Karlových Varech zahájili trestní stíhání místní šedesátileté ženy, kterou obvinili ze spáchání zločinu podvodu.
Celý článek- 24.02.2020
Děpoltovice: Střet osobního vozidla se zvěří
Na silnici 220 u obce Děpoltovice, okres Karlovy Vary, došlo k dopravní nehodě - střet osobního vozidla se zvěří. Vyšetřování nehody by mělo probíhat ještě cca hodinu.
Celý článek- 24.02.2020
Březová: Březnový program kina Admira
Kulturní dům a Multifunkční centrum Březová zveřejnilo program kina Admira na měsíc březen.
Celý článek- 24.02.2020
Cheb: Čápi už hnízdí
Včera na komín nad chebským obchodním domem Albert dorazila i samička.
Celý článek- 23.02.2020
2000 – Pomezí: Neznámý pachatel přepadl směnárnu (TV Západ)
Ve čtvrtek 10. února po 18 hodině přepadl ozbrojený pachatel obsluhu směnárny AutoArt nedaleko hraničního přechodu v Pomezí u Chebu. Dosud neznámý muž si počkal, až ve směnárně nebude žádný zákazník.
Celý článek- 23.02.2020
Nová aplikace na webu SVS usnadní vyhledávání ztracených psů
Státní veterinární správa (SVS) spustila dne 20.2.2020 na svém webu novou aplikaci. Jedná se o databázi, která umožní chovatelům a naopak nálezcům (zejména obcím, městům a útulkům) sdílet informace o ztracených a nalezených psech a tím usnadnit návrat psů k majitelům. Aplikace by měla prozatím částečně nahradit centrální registr psů, který má vzniknout od roku 2022.
Celý článek- 23.02.2020
Cheb: Na Krajince se sejdou milovníci zlatého moku
Kromě dobrého jídla si v letošním roce přijdou na své v chebském areálu Krajinka také milovníci piva. V květnu se totiž na Krajince uskuteční první ročník Festivalu piva. Ten bude výjimečný tím, že se na něj návštěvníci nepřijdou opít, ale přijdou ochutnat z opravdu široké nabídky zlatého moku.
Celý článek- 23.02.2020
Sokolov: Soutěžit lze i v memorování Ludolfova čísla
Předmětová komise přírodních věd Integrované střední školy technické a ekonomické pořádala soutěž s názvem Memorování Ludolfova čísla. Ředitel školy Pavel Janus vyhlásil cílovou odměnu ve výši 10Kč/pozice čísla za desetinnou čárkou. Zájem o účast v soutěži byl slušný, sešlo se na 20 soutěžících. Na tříkolové klání žáků a příchozích dohlíželi rozhodčí I. Pitrová, E. Borská a M. Suchan.
Celý článek- 23.02.2020
Karlovy Vary: Prodávali zboží, které jim nepatřilo
Kriminalisté z oddělení hospodářské kriminality v Karlových Varech zahájili trestní stíhání dvou mužů z Karlovarska ve věku 35 a 47 let, které obvinili ze spáchání přečinu krádeže.
Celý článek- 23.02.2020
2000 – Cheb: Strážníci pokutovali 12 klientů prostitutek (TV Západ)
Vyhláška, která od počátku roku zakazuje v Chebu nejen nabízení a poskytování sexuálních služeb na veřejných prostranstvích, ale i jejich vyhledávání a užívání, přináší první výsledky. Za více než měsíc její platnosti totiž strážníci městské policie pokutovali již 12 klientů pouličních prostitutek. Mužům, převážně ze sousedního Německa, udělili ve všech případech pokutu symbolické výše 500 korun.
Celý článek- 22.02.2020
Dalovice: Nehoda se zraněním
V Dalovicích, v ulici Dolní, část Všeborovice - u Ohře, okres Karlovy Vary, došlo k dopravní nehodě se zraněním.
Celý článek- 22.02.2020
Horní Hraničná: Drzost zlodějů nezná mezí. Okradli pejsky
Dne 21.2.2020 ve 23:15 hodin, odcizili zloději Útulku pro opuštěné psy v Horní Hraničné prkna a trámy, určené k opravám kotců a ostatního zařízení útulku.
Celý článek- 22.02.2020
V platnosti je výstraha před velmi silným větrem
Meteorologové varují před velmi silným větrem. Výstraha je v platnosti od 11:00 hodin dne 23.2.2020 do 00:00 dne 24.2.2020, a to pro kraje: Hlavní město Praha, Středočeský kraj, Jihočeský kraj, Plzeňský kraj, Karlovarský kraj.
Celý článek- 22.02.2020
2000 – Cheb: Píchnutá pneumatika vyšla cizince draho (TV Západ)
Na 55 tisíc korun přišla německého řidiče píchnutá pneumatika jeho vozu. Čtyřiapadesátiletý muž totiž při jízdě Hradební ulicí zjistil, že má prázdnou přední pneumatiku u svého Opelu Kadett. Jelikož u sebe neměl nástroje potřebné pro opravu, tak automobil zaparkoval u Okresní knihovny a vydal se hledat pomoc.
Celý článek- 22.02.2020
Workshop pomůže žadatelům s přeshraničními projekty
V Programu na podporu přeshraniční spolupráce Česká republika – Svobodný stát Sasko zbývají volné peníze. Karlovarský kraj proto ve spolupráci se Společným sekretariátem a Euregiem Egrensis pořádá 23. března od 11 hodin v Městském kulturním středisku v Plesné workshop, kde budou k dispozici zástupci dotačního programu. Přijďte zdarma konzultovat své projektové nápady a získejte cenné rady.
Celý článek- 22.02.2020
Aš: Únorovým vichrům padlo za oběť 19 stromů
Devatenáct stromů, popadaných na pozemcích města při silných poryvech větru, to je výsledek řádění přírodního živlu v průběhu měsíce února. Všechny dřeviny vítr vyvrátil či jinak poškodil kvůli jejich špatnému zdravotnímu stavu, poškozen tedy nebyl naštěstí žádný zdravý strom.
Celý článek- 22.02.2020
Bezplatné semináře s Regionální potravinou
Nevíte si rady, co všechno musí obsahovat etiketa vašeho výrobku? Tápete v oblasti legislativních požadavků na označování potravinářských výrobků? Rádi byste zkusili štěstí v 11. ročníku soutěže o značku Regionální potravina?
Celý článek- 22.02.2020
Karlovarsko: Dívka posprejovala několik objektů
Karlovarští kriminalisté zahájili trestní stíhání mladistvé dívky z Karlovarska, kterou obvinili ze spáchání provinění poškození cizí věci.
Celý článek- 22.02.2020
2000 – Cheb: Na radnici proběhlo slavnostní vyhlášení ratingu města (TV Západ)
Minulý týden došlo na chebské radnici ke slavnostnímu vyhlášení ratingu města vypracovaného specializovanou agenturou. Jedná se o komplexní zprávu, která hodnotí fakta o hospodaření města, o místní ekonomice, turistickém ruchu a dalších odvětví. Rating by měl zajistit výhodnější pozici města při jednání o dotacích či úvěrech a větší důvěryhodnost při jednání s bankami a dalšími institucemi.
Celý článek- 21.02.2020
Karlovarský kraj: Archivní zprávy 08. týdne 2020 (TV Západ)
Vysílání 21.02.2020-24.02.2020, 1. 2000 – Cheb: Na radnici proběhlo slavnostní vyhlášení ratingu města (TV Západ), 2. 2000 – Cheb: Píchnutá pneumatika vyšla cizince draho (TV Západ), 3. 2000 – Cheb: Strážníci pokutovali 12 klientů prostitutek (TV Západ), 4. 2000 – Pomezí: Neznámý pachatel přepadl směnárnu (TV Západ), 5. 2010 – Cheb: Cena za odpad zůstává pro občany stejná (3968) (TV Západ)
Celý článek- 21.02.2020
Karlovy Vary: Úmyslně poškodil vozidlo. Škoda 40 tisíc
Karlovarští kriminalisté zahájili trestní stíhání místního třiačtyřicetiletého muže, kterého obvinili ze spáchání přečinu poškození cizí věci.
Celý článek- 21.02.2020
Region: Policisté zrealizovali semináře ve zdravotnických zařízeních
V návaznosti na proběhlé události v Ostravě policisté z odboru služby pořádkové policie ve spolupráci s oddělením psychologických služeb Krajského ředitelství policie Karlovarského kraje zrealizovali během měsíce ledna a února v pěti nemocnicích v Karlovarském kraji semináře pod názvem „Ozbrojený útočník ve zdravotnickém zařízení.“
Celý článek- 21.02.2020
Sokolov: Březnový program Městského domu kultury a kina Alfa
28. března, sobota, 18:00, Městské divadlo Sokolov - ROHÁČI 45 - Slavná loketská folková formace slaví neuvěřitelné výročí svého trvání. K oslavě si pozvala hudební hosty Radka Tomáška a skupinu Ozvěna Brno.
Celý článek- 21.02.2020
Vysoká kvalita potravin značky Klasa a Regionální potravina
Potravinářská inspekce pravidelně realizuje kontrolní akci zaměřenou na potraviny oceněné značkou KLASA a Regionální potravina. Výsledky za rok 2019 opět potvrdily jejich velmi vysokou jakost a bezpečnost.
Celý článek- 21.02.2020
Potůčky: Ze Skiareálu byla odcizena čtyřkolka
"Dnes v noci 21.2. nám byla odcizena čtyřkolka Can-Am Outlander Max XTP 800 na pásech (r.v. 2009). Pokud ji zahlédnete někde na silnici, na vleku, apod., prosím kontaktujte 353 579 141 nebo linku 158," uvádí na svých facebookových stránkách SKIPOT Skiareál Potůčky.
Celý článek- 21.02.2020
Cheb: S prodavačkou si domluvili nákupy zdarma
Zaměstnancem roku se určitě nestane teprve devatenáctiletá žena z Chebu, která pracovala v jednom z místních obchodních domů. Po domluvě s ní do obchodu chodil nakupovat třicetiletý muž se svou pětatřicetiletou ženou.
Celý článek- 21.02.2020
Karlovy Vary: Policisté pátrají po svědcích dopravních nehod
Karlovarští dopravní policisté pátrají po svědcích dopravní nehody, ke které došlo dne 19. února 2020 kolem deváté hodiny ranní v Karlových Varech na ulici Závodu Míru č. 102 v blízkosti křižovatky s ulicí Svobodova.
Celý článek- 21.02.2020
Cheb: Radní Licková rezignovala na svůj mandát
Na včerejším zasedání Zastupitelstva města Chebu oznámila paní RNDr. Gabriela Licková, Ph.D. rezignaci na funkci radní a zastupitelky. Za její dosavadní práci ve prospěch města a jeho občanů jí představitelé chebské radnice děkují a přejí hodně zdaru v další činnosti i v osobním životě.
Celý článek- 21.02.2020
Otovice: Muž se po nehodě nemohl dostat z vozu ven
Dnes okolo 10:40 hodin došlo u obce Otovice, okres Karlovy Vary, k dopravní nehodě. Muž se po nehodě nemohl dostat z vozu ven. Na místě stále zasahují PČR, ZZS a HZS.
Celý článek- 21.02.2020
Sokolov: Veletrh fiktivních firem podvanácté (TV Západ)
Již 12. ročník přehlídky fiktivních firem se uskutečnil v prostorách Městského domu kultury v Sokolově ve středu 5. února. Přípravy na tuto každoroční akci zahájila Střední škola živnostenská Sokolov již v říjnu loňského roku.
Celý článek- 21.02.2020
Cheb: Rekonstrukce Družstevní ulice vyjde na 4,8 milionu
Na úterním setkání v jídelně 1. ZŠ byli občané Skalky seznámeni s rekonstrukcí Družstevní ulice, která bude zahájena v nejbližších dnech. Upravovat se bude část ulice od křížení s takzvanou alejí směrem ke křižovatce s ulicí Přátelství.
Celý článek- 21.02.2020
Máte rádi cestování a svobodu? Vyzkoušejte komfortní obytné značky Rimor!
Nabízíme obytné vozy značky Rimor, které můžete využít jako komfortní hotel na kolech pro vaši dovolenou.
Celý článek- 21.02.2020
Sokolovsko: Kvůli psovi napadli muže
Na začátku prosince minulého roku měl mít před panelovým domem v jedné menší obci na Sokolovsku spor nezletilý chlapec s padesátiletým mužem. Chlapec měl na muže začít křičet a vyčítat mu, že nemá psa na vodítku.
Celý článek- 21.02.2020
Hasiči Ostrov předali Radečkovi z Plesné 15 tisíc
Členové výjezdové jednotky Ostrov mezi sebou vybrali částku 15 tisíc korun, kterou předali malému Radečkovi z Plesné.
Celý článek- 20.02.2020
Region: Kraj vybere nového dodavatele rekonstrukce nemocnice Cheb (TV Západ)
V listopadu loňského roku odstoupil Karlovarský kraj jako investor do smlouvy se zhotovitelským sdružením firem od rekonstrukce pavilonu B chebské části Karlovarské krajské nemocnice. Pro výběr nového dodavatele nyní musí kraj upravit a rozdělit projektovou dokumentaci podle skutečného stavu rozpracované zakázky.
Celý článek- 20.02.2020
Střední lesnická škola Žlutice se dočká další modernizace
V květnu letošního roku by se naplno měly rozjet stavební práce na rekonstrukci bývalé kotelny a stodoly ve Střední lesnické škole Žlutice. Rada Karlovarského kraje na svém zasedání schválila realizaci zadávacího řízení na realizaci stavby. Předpokládané náklady jsou vyčísleny na více jak 10,8 milionu korun včetně DPH.
Celý článek- 20.02.2020
Sokolov: Devatenáctiletý muzikant složil znělku pro město
Město Sokolov má svou oficiální skladbu nazvanou Znělka pro Sokolov. Poprvé veřejně zazněla 15. února při Plesu města Sokolov. Složil ji teprve devatenáctiletý muzikant Michal Kopecký ze Sokolova.
Celý článek- 20.02.2020
Karlovy Vary: MHD mění jízdní řády
Městská hromadná doprava v Karlových Varech vyjede 1. března podle nových jízdních řádů. Jejich úprava reflektuje potřebu zajistit efektivnější provoz, návaznost spojů a lepší obslužnost frekventovaných lokalit. Některé minimálně využívané spoje budou zrušeny, naopak přibudou nové.
Celý článek- 20.02.2020
Sokolovsko: Dva chlapci se vloupali do sklepní kóje
Kriminalisté z druhého oddělení obecné kriminality v Sokolově zahájili trestní stíhání dvou mladistvých chlapců ze Sokolovska, které obvinili ze spáchání provinění krádeže a porušování domovní svobody. Takového protiprávního jednání se měli dopustit koncem září minulého roku v malé obci na Sokolovsku.
Celý článek- 20.02.2020
Orkán Sabine - 306 tisíc odběratelů bez elektřiny
Přetrhané vodiče, popadané sloupy a stožáry elektrického vedení, poškozené distribuční trafostanice, ulomené izolátory. Vyhlášený kalamitní stav v sedmi krajích, 306 tisíc odběratelů bez elektřiny, 2755 poruch na elektrickém vedení, 500 energetiků v terénu, 30 tisíc přijatých hovorů na call centru, škody na distribučním zařízení za 25 milionů korun. ČEZ Distribuce vyčíslila škody po orkánu Sabine.
Celý článek- 20.02.2020
Kraslice: Osobní vozidlo narazilo do sloupu veřejného osvětlení
Osobní auto havarovalo ve středu odpoledne v Kraslicích. Narazilo do sloupu veřejného osvětlení. Při nehodě se zranila jedna osoba. Hasiči zajistili místo nehody a zlikvidovali únik provozních kapalin.
Celý článek- 20.02.2020
Meteorologově opět varují přes silným větrem
Výstraha je v platnosti od 03:00 do 11:00 hodin dne 21.2.2020 a platí pro kraje: Hlavní město Praha, Středočeský kraj, Jihočeský kraj, Plzeňský kraj, Karlovarský kraj, Ústecký kraj, Liberecký kraj.
Celý článek- 20.02.2020
2010 – Sokolov: Vývařovna na 5. ZŠ by se měla rozšířit (3972) (TV Západ)
Město Sokolov chce řešit situaci ohledně stravování školáků na druhé základní škole. Ta nemá vlastní kuchyň a žákům tam ve výdejně podávají jídlo od soukromé firmy. Loni zastupitelstvo odmítlo velký projekt centrální vývařovny na 5. ZŠ s kapacitou 2000 jídel. Důvodem byla cena nákladných stavebních úprav i dodávka nové technologie.
Celý článek- 20.02.2020
Ministr vnitra předal policistům 30 vozidel
Ve středu dne 19. února 2020 v odpoledních hodinách předal ministr vnitra Jan Hamáček za účasti ředitele Krajského ředitelství policie Karlovarského kraje plk. Mgr. Petra Macháčka, statutárního náměstka hejtmana Karlovarského kraje Martina Hurajčíka a primátorky města Karlovy Vary Ing. Andrey Pfeffer Ferklové, MBA policistům Karlovarského kraje tři desítky nových vozidel.
Celý článek- 20.02.2020
Karlovarsko: Pod vlivem alkoholu řešili spory násilím
Policisté z Obvodního oddělení Karlovy Vary – město sdělili dvěma mužům z Karlovarska ve věku 19 a 31 let podezření ze spáchání přečinu výtržnictví. Takového jednání se měli dopustit v polovině února tohoto roku ve večerních hodinách v Karlových Varech. Po předchozí slovní rozepři před místním barem se měli nejprve vzájemně fyzicky napadat.
Celý článek- 20.02.2020
Kraj vyhlásil veřejnou sbírku pro paní Vlastu Krejčovou
Vedení Karlovarského kraje se rozhodlo vyhlásit veřejnou sbírku, do které mohou zájemci přispět prostřednictvím zapečetěných sběracích pokladniček nebo na speciálně zřízený bankovní účet. Sbírka je zaměřena na pořízení zdvihací plošiny pro paní Vlastu Krejčovou z Chebu, která je upoutána na invalidní vozík a bydlí v panelovém domě bez výtahu.
Celý článek- 19.02.2020
Sokolov: Sklepení zámku ukáže graffiti ze 17. století (TV Západ)
V letech 2017 až 2019 proběhly v sokolovském zámku přípravné a následně stavební práce pro zpřístupnění suterénu pod jižním a částečně i východním křídlem. Náklady na zpřístupnění sklepení byly financovány Karlovarským krajem a Městem Sokolov. Během stavebních prací byly znovu odkryty části hradby původního sokolovského hradu z poloviny 13.století nalezené archeologickým výzkumem v roce 1993 a na renesančních omítkách byly odhaleny tři typy rytých záznamů – graffiti ze 17. století.
Celý článek- 19.02.2020
Cheb: Nejstarší občanka města slaví 102 let
Dnes byl starosta města Antonín Jalovec poblahopřát ke krásnému životnímu jubileu sto dva let paní Alžbětě Slavíčkové. V chebské léčebně dlouhodobě nemocných Amica žije oslavenkyně již šestým rokem. Stále se těší dobrému zdraví a v domově je velmi spokojena.
Celý článek- 19.02.2020
Boží Dar: Policie rozdávala reflexní předměty návštěvníkům hor
Jako každý rok proběhl na Božím Daru během uplynulého víkendu ve dnech 15. – 16. února 2020 jeden z nejstarších běžeckých závodů na lyžích v Čechách. Ten se v tomto místě koná již od konce 60. let a letos to byl již 49. ročník.
Celý článek- 19.02.2020
Meteorologové varují před náledím
Výstraha je v platnosti od dnešního dne od 21:00 hod. do 20.2.2020 do 09:00 hodin.
Celý článek- 19.02.2020
Handy Cyklo Maraton opět zamíří do našeho regionu
Oblíbený pětidenní nonstop cyklistický závod, v němž se společně na trať vydávají zdraví i handicapovaní cyklisté, opět zavítá do našeho regionu. Radní pro oblast tělovýchovy a sportu Josef Váňa se 14.2.2020 sešel s organizátorem akce a zástupcem spolku Cesta za snem Heřmanem Volfem.
Celý článek- 19.02.2020
Chebsko: Prodejce podvedl 400 zákazníků
Chebští kriminalisté intenzivně pátrají po nepoctivém prodejci. Ten měl od 5. prosince 2019 do 12. prosince 2019 provozovat internetový obchod www.techtronic.cz, kde byla zákazníkům nabízena spotřební elektronika.
Celý článek- 19.02.2020
Region: Policie pátrá po Ludvíku Gabrielovi a Danielu Valovičovi
Chebští kriminalisté pátrají po 38letém muži z Chebu, který je asi 180-185 cm vysoké atletické postavy, má prošedivělé krátce střižené vlasy, prošedivělé vousy upravené do tzv. bradky či plnovousu a hnědé oči.
Celý článek- 19.02.2020
2010 – Cheb: Revitalizace Zlatého vrchu pokračuje (3975) (TV Západ)
Velký projekt revitalizace chebského sídliště Zlatý vrch pokračuje prozatím v přípravách dílčích projektů. Program nazvaný Integrovaný projekt rozvoje města zatím uzavřel tři výzvy k podání žádostí o dotace. Jedna z výzev se týkala úpravy komunikací. Ta je průběžná a může žádat pouze město na revitalizaci, budování parkovacích míst nebo úpravu cest. Další dvě výzvy se týkaly vnějších částí budov, zateplení, výměny oken a opravy střech. Těchto dvou výzev se mohli účastnit také vlastníci domů.
Celý článek- 19.02.2020
Chebsko: Hyena. Trýznil svou 72letou matku
Chebští kriminalisté zahájili trestní stíhání místního pětačtyřicetiletého muže, kterého obvinili ze spáchání přečinů nebezpečného vyhrožování, vydírání, neoprávněného zásahu do práva k domu a maření výkonu úředního rozhodnutí a vykázání.
Celý článek- 19.02.2020
Region: Policisté zkontrolovali 900 vozidel
Alkohol či jiné návykové látky nepatří za volant řidičů. Z tohoto důvodu proběhla během pátečního večera, dne 14. února 2020, dopravně bezpečnostní akce „Y“ zaměřená především na alkohol a jiné návykové látky u řidičů.
Celý článek- 19.02.2020
Chebsko: Peníze si vzal, ale střechu nedokončil
Chebští kriminalisté zahájili trestní stíhání třicetiletého muže z Františkových Lázní, kterého obvinili ze spáchání přečinu zpronevěry.
Celý článek- 19.02.2020
Sokolovsko: Vloupali se do chaty. Měsíc v ní pobývali
Policisté z Obvodního oddělení Habartov sdělili šestatřicetileté ženě a o dva roky staršímu muži ze Sokolovska podezření ze spáchání přečinu porušování domovní svobody.
Celý článek- 18.02.2020
Cheb: Vysoká škola otevře možnosti nekvalifikovaným učitelům (TV Západ)
Vývoj situace s rozšiřováním vysoké školy v Chebu je zatím pro vedení města spíše zklamáním. Z celé řady plánovaných oborů zatím vypadají nadějně pouze pedagogická studia pro nekvalifikované učitele prvního stupně základních škol.
Celý článek- 18.02.2020
Sokolov: Prostranství u střediska se změní v důstojný prostor
Revitalizaci současné podoby prostranství u zdravotnického střediska mezi ulicemi Závodu míru a Marie Majerové připravuje město Sokolov.
Celý článek- 18.02.2020
Karlovy Vary: Svou družku několikrát kopl do hlavy
Kriminalisté z druhého oddělení obecné kriminality v Karlových Varech zahájili trestní stíhání 29letého muže z Karlovarska, kterého obvinili ze spáchání přečinu ublížení na zdraví.
Celý článek- 18.02.2020
Region: Mladí youtubeři mohou zkusit štěstí v soutěži
Karlovarská agentura rozvoje podnikání pořádá již 2. ročník soutěže pro žáky základních, středních a vysokých škol v Karlovarském kraji. Cílem soutěže je vzbudit kreativního ducha, ale i podpořit lokální patriotismus v rámci kampaně Žijeme regionem (www.zijemeregionem.cz).
Celý článek- 18.02.2020
Sokolov: Srazil chodkyni. Na místo nehody letěl vrtulník
Sokolovští dopravní policisté pátrají po svědcích dopravní nehody, která se stala v úterý 21. ledna letošního roku kolem 18:08 hodin v ulici K. H. Borovského v Sokolově, konkrétně na tzv. Chemičáku. Při dopravní nehodě, při které řidič vozidla Škoda nepřizpůsobil rychlost jízdy svým schopnostem, vlastnostem vozidla a povětrnostním podmínkám, došlo ke střetu automobilu a chodkyně.
Celý článek- 18.02.2020
Sokolovsko: Na manželku vytáhl nůž
Sokolovští kriminalisté zahájili trestní stíhání šedesátiletého muže z jedné menší obce na Sokolovsku, kterého obvinili ze spáchání přečinu nebezpečného vyhrožování.
Celý článek- 18.02.2020
Karlovy Vary: Na hokeji se dopouštěli výtržnosti. Napadli i ostrahu
Během pátečního hokejového utkání v Karlových Varech dva fanoušci jednoho z týmů ve věku 22 a 28 let svým chováním na zimní stadionu porušovali návštěvní řád.
Celý článek- 18.02.2020
2010 – Sokolov: Město koupilo pozemek na záchytné parkoviště (3970) (TV Západ)
Město Sokolov koupilo pozemek pro plánované záchytné parkoviště. Jedná se o místo nedaleko polikliniky sousedící s pozemky automotoklubu.
Celý článek- 18.02.2020
Bavorsko-český den pro firmy se uskuteční již počtvrté
Rozšiřte svou kontaktní síť mezi dolnobavorskými a českými aktéry v oblasti ekonomiky a vědy. Prezentujte se na veletrhu společně s dalšími firmami, vysokými školami, klastry a organizacemi, nebo se zúčastněte jako host a využijte možnost osobního kontaktu.
Celý článek- 18.02.2020
Čištění řeky Ohře se bude konat již popáté
Místní akční skupiny Karlovarského kraje Vás zvou na 5. ročník akce Čištění řeky Ohře. Čistit může každý, kdo má zájem udělat něco pro životní prostředí a náš region.
Celý článek- 18.02.2020
Konference ukáže, jak se v kraji pečuje o památky
Ukázky příkladné péče o kulturní dědictví regionu i vybrané projekty se představí na 4. ročníku konference "Péče o památky a krajinu v Karlovarském kraji."
Celý článek- 17.02.2020
Karlovarský kraj: Zprávy 08. týdne 2020 (TV Západ)
Vysílání 17.02.2020-21.02.2020, 1. Cheb: Vysoká škola otevře možnosti nekvalifikovaným učitelům (TV Západ), 2. Sokolov: Sklepení zámku ukáže graffiti ze 17. století (TV Západ), 3. Region: Kraj vybere nového dodavatele rekonstrukce nemocnice Cheb (TV Západ), 4. Sokolov: Veletrh fiktivních firem podvanácté (TV Západ), 5. Region: Nejkrásnější železnice vybral The Guardian (TV Kraj)
Celý článek- 17.02.2020
Karlovy Vary: Jezdecká socha Karla IV. vyjde na 8 milionů
Realizační tým pomníku Karla IV. v Karlových Varech spouští dne 13. 2. webové stránky s transparentním účtem, na němž se v průběhu prvního měsíce nashromáždilo necelých 700 tisíc korun z celkové částky 8 milionů korun, které jsou potřeba k realizaci jezdecké sochy římského císaře a českého krále.
Celý článek- 17.02.2020
Sokolov: Ohňostroje budou jen při akci Hurá prázdniny
O jakém z bodů programu prvního letošního jednání zastupitelstva města se bude nejvíce debatovat? Kdo si vsadil na rozhodování, jestli pořádat nebo nepořádat soutěž ohňostrojů, ten vyhrál. Poměrně bouřlivá diskuze, do níž vstupovali odpůrci i zastánci ohňostrojů, nakonec vyzněla pro tuto atrakci, ovšem s kompromisem.
Celý článek- 17.02.2020
Region: Počet nemocných respirační infekcí klesá
Nemocnost akutních respiračních infekcí (dále jen „ARI“) v Karlovarském kraji vychází z týdenních hlášení praktických lékařů pro dospělé a praktických lékařů pro děti a dorost. Jedná se o vážená a standardizovaná data s využitím počtu obyvatel v jednotlivých okresech a jednotlivých věkových skupinách.
Celý článek- 17.02.2020
Milíkov: Práce na rekonstrukci hrázděného statku pokračují
Po zimní přestávce se opět rozjely stavební práce na rekonstrukci památkově chráněného hrázděného statku v Milíkově na Chebsku. Objekt, který je opravován dobovými technikami, bude po dokončení ukázkou chebského statku z přelomu 18. a 19. století. Doplní jej nová expozice.
Celý článek- 17.02.2020
Karlovarský kraj nakoupil ochranné pomůcky jako humanitární pomoc Číně
"Rada Karlovarského kraje schválila nákup ochranných pomůcek do výše 100 tisíc korun jako humanitární pomoc Číně, kde se velmi rychle šíří nákaza koronavirem a smrtící virus už si vyžádal stovky obětí," uvedl hejtman Karlovarského kraje Petr Kubis.
Celý článek- 17.02.2020
V České republice bylo objeveno druhé ohnisko ptačí chřipky
Státní veterinární správa (SVS) vyhlásila letošní druhé ohnisko ptačí chřipky v České republice. Ohnisko nákazy se nachází ve velkochovu drůbeže společnosti Moras Moravany v obci Slepotice na Pardubicku. Jde o vysoce patogenní subtyt H5N8, smrtelný pro ptáky, nicméně jeho přenos na člověka nebyl dosud zaznamenán.
Celý článek- 17.02.2020
Rotava: Nalezli SIM kartu. Za dva týdny provolali šest tisíc
Policisté z Obvodního oddělení Rotava sdělili podezření ze spáchání přečinu podvodu sedmadvacetiletému muži a šestadvacetileté ženě z Kraslic.
Celý článek- 17.02.2020
2010 – Cheb: Kamerový systém se rozšíří i na Zlatý vrch (3965) (TV Západ)
Rozšíření kamerového systému v Chebu připravuje město v tomto roce. Stávajících deset kamer posílí poprvé systém mimo centrum města, a to na sídlišti Zlatý vrch.
Celý článek- 17.02.2020
Hledáte specialisty na pravidelný úklid SVJ? Máme pro vás dobrou zprávu!
Zajišťujeme profesionální úklid prostorů SVJ v Plzni a nabízíme akce pro nové zákazníky!
Celý článek- 17.02.2020
Nejdek: Způsobil dopravní nehodu. Z místa ujel
Kriminalisté z druhého oddělení obecné kriminality v Karlových Varů zahájili trestní stíhání 25letého muže z Chebska, kterého obvinili ze spáchání přečinu maření výkonu úředního rozhodnutí a vykázání.
Celý článek- 17.02.2020
Cheb: Napadený muž musel být hospitalizován v nemocnici
Chebští kriminalisté zahájili trestní stíhání devatenáctiletého muže ze Sokolovska, kterého obvinili ze spáchání přečinů ublížení na zdraví a výtržnictví.
Celý článek- 17.02.2020
Cheb: Město hledá pro letošní rok vánoční strom
Město Cheb hledá dárce vhodného vánočního stromu, který bude na konci letošního roku zdobit náměstí Krále Jiřího z Poděbrad. Strom by měl být ve vzdálenosti do 40 kilometrů od Chebu a na místě přístupném těžké technice (nákladní automobil s přívěsem a jeřáb).
Celý článek- 16.02.2020
2000 – Mariánské Lázně: Vyroste nový lázeňský komplex Globus? (TV Západ)
Stavbu společensko-rehabilitačního centra chystá ještě v letošním roce začít akciová společnost Léčebné lázně Mariánské Lázně. V novém komplexu Globus, který vyroste v proluce léčebného domu Skalník, budou moci pacienti i veřejnost využít mj. plavecký bazén a kompletní balneologické služby včetně masáží a parní lázně. V současné době probíhá územní řízení a výstavba by měla být zahájena na podzim.
Celý článek- 16.02.2020
Březová u Karlových Varů: Část skály se zřítila na silnici
Na silnici I/20 u přehrady Březová u Karlových Varů se v sobotu (15.2.) odpoledne zřítila část skály. I přes síťové zábrany se kameny dostaly až na silnici. Silničáři místo hned uklidili. Zjišťují však, proč k pádu i přes zábrany došlo.
Celý článek- 16.02.2020
Kraj vybral zpracovatele územní studie pro Krušné hory
Zpracovatelem Územní studie Krušné hory - západ (dostupnost rekreace) se na základě výsledku výběrového řízení stane Architektonické studio Hysek, s. r. o. z Plzně. Jeho úkolem bude připravit územní plánovací podklad, který zahrne aktuální vývojové trendy Krušnohoří, pomůže obcím vyhodnotit dopady změn v území a zkoordinovat své aktivity.
Celý článek- 16.02.2020
Region: Na opravy silnic půjde letos navíc 100 milionů
Karlovarský kraj přidá z přebytku rozpočtu z minulého roku 100 milionů korun na opravy krajských silnic, tedy silnic druhé a třetí třídy.
Celý článek- 16.02.2020
2000 – Chebsko: Zemědělská škola oslavila 40 let (TV Západ)
Minulý víkend se uskutečnily oslavy založení chebské zemědělské školy, dnes Střední odborné školy.
Celý článek- 16.02.2020
Chebsko: Za tři školní období zameškala více než 900 hodin
Povinnost řádně zabezpečovat povinnou školní docházku nezletilé dcery, která vyplývá ze zákona o rodině, vzali nejspíš na lehkou váhu 30letý muž a 35letá žena z Chebska. Svoji nezletilé dceři měli umožnit vést zahálčivý život tím, že nezajistili její povinnou školní docházku.
Celý článek- 16.02.2020
2000 – Františkovy Lázně: Požár domu si vyžádal jednu oběť (TV Západ)
K požáru rodinného domku, jehož obětí se stala 50letá žena, došlo ve Františkových Lázních, v části Horní Lomany, v Budovatelské ulici. Příčinou požáru byla chybně vedená roura kouřovodu od kamen, která se nacházela v těsné blízkosti šatní skříně. Ta se vznítila od sálavého tepla a plameny zachvátily chodbu domu v přízemí.
Celý článek- 15.02.2020
2000 – Cheb: Město na výstavbu bytů vyčlenilo 8 milionů (TV Západ)
Chebská radnice si za jednu ze svých priorit v rozvojovém programu města vytyčila podporu bytové výstavby. Vždyť posledních, přibližně 200 nových bytů na sídlišti Zlatý vrch, bylo dáno do užívání již v letech 1995 až 1997. Rozjezd výstavby nových bytů si klade za svůj cíl rovněž nový místostarosta Pavel Vanoušek.
Celý článek- 15.02.2020
Stále více turistů míří do Karlovarského kraje
V roce 2019 se v hromadných ubytovacích zařízeních v Karlovarském kraji ubytovalo celkem 1 193 555 hostů, což je o 6,8 procenta více než v předcházejícím roce. Podle dat zveřejněných Českým statistickým úřadem se zvýšil jak počet domácích hostů, tak i těch, kteří přijeli ze zahraničí.
Celý článek- 15.02.2020
V Chebu opět připravují tradiční masopustní průvod
Rádi se bavíte a chcete si zavzpomínat na staré tradice? Pak si rozhodně nenechte ujít masopustní průvod, který se vydá na svoji cestu historickou částí Chebu v sobotu 29. února. A nezapomeňte, jsou to právě masky, které jsou jeho největší ozdobou.
Celý článek- 15.02.2020
Velká Hleďsebe: Pozor! Nehoda se zraněním
Ve Velké Hleďsebi, okres Cheb, došlo k dopravní nehodě se zraněním - střet tří vozidel.
Celý článek- 15.02.2020
2000 – Františkovy Lázně: Mladík utrpěl při nehodě smrtelná zranění (TV Západ)
Již ke čtvrté smrtelné nehodě od počátku roku došlo na silnicích Chebska. Prozatím poslední obětí se stal 21letý řidič dodávkového vozidla Ford Transit patřícího poště. Tento muž havaroval při cestě z Chebu do Aše v blízkosti Františkových Lázní, v místě za odbočkou na Třebeň.
Celý článek- 15.02.2020
Mariánské Lázně: Své družce přiložil nůž ke krku
Kriminalisté z druhého oddělení obecné kriminality v Chebu zahájili trestní stíhání dvaačtyřicetiletého cizince, kterého obvinili ze spáchání zločinu vydírání.
Celý článek- 15.02.2020
2000 – Mariánské Lázně: Největší epidemie salmonelózy v republice (TV Západ)
Největší epidemie salmonelózy v České republice za posledních deset let postihla v minulém týdnu Mariánské Lázně. Pozdější laboratorní testy potvrdily, že původcem nákazy byl oběd ve školní jídelně 1. ZŠ, ke kterému byl podáván bramborový salát s kuřecím řízkem.
Celý článek- 14.02.2020
Karlovarský kraj: Archivní zprávy 07. týdne 2020 (TV Západ)
Vysílání 14.02.2020-17.02.2020, 1. 2000 – Mariánské Lázně: Největší epidemie salmonelózy v republice (TV Západ), 2. 2000 – Františkovy Lázně: Mladík utrpěl při nehodě smrtelná zranění (TV Západ), 3. 2000 – Cheb: Město na výstavbu bytů vyčlenilo 8 milionů (TV Západ), 4. 2000 – Františkovy Lázně: Požár domu si vyžádal jednu oběť (TV Západ), 5. 2000 – Chebsko: Zemědělská škola oslavila 40 let (TV Západ),
Celý článek- 14.02.2020
Sokolov: V nemocnici vznikne nové Transfuzní dárcovské centrum
Nemocnice Sokolov otevře na začátku 2. čtvrtletí letošního roku nové moderní Transfuzní dárcovské centrum. Budovaná transfuzní stanice v nevyužitých prostorách pavilonu C bude sloužit nejen pro odběry krve, ale i krevní plazmy a také jako registr dárců kostní dřeně. Do revitalizace a vybavení místností provozovatel nemocnice, společnost Penta Hospitals CZ, investuje řádově miliony korun.
Celý článek- 14.02.2020
Stará Voda: U obce havarovala dvě auta. Záchranáře zavolal systém eCall
U dopravní nehody dvou osobních aut zasahovali hasiči ve čtvrtek večer u Staré Vody na Mariánskolázeňsku. S voláním o pomoc pomohl systém eCall. Ani jedno z havarovaných aut tento systém nemělo, u nehody ale zastavil svědek, který systém eCall aktivoval na svém vozidle ručně.
Celý článek- 14.02.2020
Ostrov: Neunesl rozchod. Ženu bil do celého těla
Policisté z Obvodního oddělení Ostrov sdělili 23letému muži z Karlovarska podezření ze spáchání přečinů ublížení na zdraví spáchaného ve stádiu pokusu a porušování domovní svobody.
Celý článek- 14.02.2020
Nejdek: Převrácené vozidlo. Únik pohonných hmot
V Nejdku, v ulici Kraslická, došlo k dopravní nehodě, kdy zde havarovalo osobní vozidlo - auto je převrácené + došlo k úniku pohonných hmot.
Celý článek- 14.02.2020
Region: Policisté odhalili 11 nelegálně převážených cizinců
Nejnovější pomocník odboru cizinecké policie Karlovarského kraje pomohl odhalit 11 běženců uschovaných v nákladním prostoru kamionu. V noci ze čtvrtka na pátek ve dnech 13. – 14. února 2020 prováděli policisté cizinecké policie ve spolupráci s dopravními policisty a celní správou kontrolní akci pod názvem „Kamion,“ která probíhá od ledna tohoto roku na celém území České republiky.
Celý článek- 14.02.2020
Nové Sedlo: Policisté pomohli těhotné ženě
Ve středu 12. února 2020 policisté prap. Roland Veršecký a prap. Tomáš Knopp z Obvodního oddělení Chodov byli kolem půl deváté hodiny ranní operačním důstojníkem vysláni k dopravní nehodě na silnici III. třídy č. 2092.
Celý článek- 14.02.2020
Pohřešovaný 28letý muž
Byli jsme požádáni o pomoc při pátrání po 28letém Romanu Hrabovském. Pokud jste pohřešovaného viděli, obraťte se na nejbližší policejní služebnu či volejte linku 158.
Celý článek- 14.02.2020
Aš: Ve městě shořela skladovací hala
V noci ze čtvrtka na pátek krátce před půlnocí začala hořet skladovací hala v Aši. V době příjezdu hasičů na místo události byla již celá hala zasažená plameny. Uvnitř haly bylo několik vozidel a motorek, během likvidace požáru uvnitř hasiči našli rovněž tlakové lahve.
Celý článek- 14.02.2020
Sokolov: Ve městě se letos modernizuje 38 zastávek MHD (TV Západ)
Plán na výměnu 38 zastávek MHD má město Sokolov. Ty současné jsou z velké části dožilé a nesplňují nároky na provoz.
Celý článek- 14.02.2020
Student z Mariánek zvítězil v celorepublikovém finále Kvízu PLUS
Na půdě Ministerstva vnitra ČR proběhlo 10. února celorepublikové finále soutěžního Kvízu PLUS. Dvanáct vítězů krajských kol mezi sebou poměřilo síly, přičemž správnost zodpovězených otázek a nejrychlejší čas odpovědí rozhodly o absolutním vítězi. Karlovarský kraj gratuluje Stanislavu Knaizlovi z Gymnázia a obchodní akademie Mariánské Lázně k prvenství v soutěži, která je součástí projektu Kraje pro bezpečný internet.
Celý článek- 14.02.2020
Sokolovsko: Nákup platila nalezenými platebními kartami
Sokolovským policistům se podařilo dopadnout nepoctivého nálezce pouzdra s osobními doklady a platebními kartami. Jeho ztrátu letošního února nahlásil čtyřiapadesátiletý muž ze Sokolova.
Celý článek- 14.02.2020
Nová Role: Mladá žena prodávala marihuanu
Kriminalisté z druhého oddělení obecné kriminality v Karlových Varech zahájili trestní stíhání jednadvacetileté ženy z Karlovarska, kterou obvinili ze spáchání přečinu nedovolená výroba a jiné nakládání s omamnými a psychotropními látkami a s jedy.
Celý článek- 13.02.2020
Cheb: Modely vláčků přilákaly přes 3 tisícovky návštěvníků (TV Západ)
První únorový víkend se v chebském Kulturním centru Svoboda odehrál ve znamení modelů vláčků. Klub železničních modelářů Praha 3 představil modely kolejišť, které jsou prací členů klubu - dospělých i dětí a jsou zhotoveny podle reálných vzorů s převahou ruční práce.
Celý článek- 13.02.2020
Mariánské Lázně: Pozor v lázeňských lesích a městských parcích
Město upozorňuje, abyste dbali zvýšené opatrnosti při pohybu v lázeňských lesích z důvodu působení orkánu Sabine na lesní porosty.
Celý článek- 13.02.2020
Nemocnice v Karlových Varech a v Chebu budou mít nové moderní přístroje
Potřebnou obnovu přístrojového vybavení karlovarské a chebské nemocnice zafinancuje Karlovarský kraj. Pokud to schválí krajské zastupitelstvo, navýší se základní jmění Karlovarské krajské nemocnice o 20 milionů korun právě na pořízení nových přístrojů. Kromě toho dojde k renovaci či k nákupu nové magnetické rezonance. Zkrátí se tak čekací doba pacientů na vyšetření.
Celý článek- 13.02.2020
Chodov: Zázemí pečovatelského domu bude upraveno
Chodov plánuje rekonstrukci hospodářské budovy přilehlé k domu s pečovatelskou službou. V budoucnu by tam měly být sociálně terapeutické dílny pro Mateřídoušku, další část by pak sloužila jako nové zázemí pro pečovatelský dům.
Celý článek- 13.02.2020
Rotava: Občané města přicházejí o bydlení
Když před časem Město Rotava začalo vykupovat od různých vlastníků byty, v nichž žijí lidé sociálně vyloučení nebo vyloučením ohrožení, jevilo se to jako dobrá věc. Město se tak snažilo odříznout obchodníky s chudobou a současně se tak snažilo regulovat rotaci lidí. Čím více sociálně vyloučení migrují mezi městy v regionu, tím více problémů za sebou zanechávají.
Celý článek- 13.02.2020
Sokolov: Karel Mlejnek povede reprezentační dvacítku
HC Baník Sokolov gratuluje Karlovi Mlejnkovi ke jmenování do pozice hlavního trenéra české juniorské reprezentace. Tento krok je vnímán i jako pocta pro celý klub. Současný hlavní trenér A-týmu a sportovní manažer klubu má v klubu smlouvu do 30. 4. 2020.
Celý článek- 13.02.2020
Toužim: Inspektoři v Penny Marketu našli mrtvé myši
Včera, dne 12.2.2020, byla uzavřena provozovna Penny Market v Toužimi, Plzeňská 581, a to z důvodu výskytu myšího trusu, mrtvých myší a výrazně zanedbaného úklidu.
Celý článek- 13.02.2020
Kraj se ohrazuje proti nepravdivým informacím ohledně Střední školy živnostenské Sokolov
Mezi veřejností se šíří mylné zprávy ohledně budoucnosti Střední školy živnostenské Sokolov. Rodiče a žáci mají obavy z toho, že dojde k jejímu sloučení s Integrovanou střední školou technickou a ekonomickou Sokolov či k jejímu úplnému zrušení. Jak uvedl radní pro oblast školství a mládeže Jaroslav Bradáč, Karlovarský kraj se jako zřizovatel školy k žádnému takovému kroku nechystá.
Celý článek- 13.02.2020
Karlovy Vary: Střet dvou vozidel
V Karlových Varech, v ulici Mattoniho nábřeží 351/82 došlo k dopravní nehodě bez zranění - střet dvou vozidel. Průjezd je možný se zvýšenou opatrností - překážka na vozovce. Na místo jede PČR.
Celý článek- 13.02.2020
2010 – Cheb: Veřejná sbírka na opravu vyhlídkového altánu (3957) (TV Západ)
Nadační fond Historický Cheb již vyhlásil další veřejnou sbírku. Po velmi sledovaném a úspěšném projektu obnovy věží kostela sv. Mikuláše je to nyní obnova vyhlídky na Zlatém vrchu. Torzo altánu a přilehlé Dvořákovy sady se nachází v místě, odkud je při dobrém počasí možné vidět historické jádro města.
Celý článek- 13.02.2020
Sokolovsko: Své manželce vyhrožoval zabitím
Ke konci listopadu minulého roku v Sokolově nastoupila osmačtyřicetiletá žena do svého vozu s úmyslem odjet do zaměstnání. V té chvíli k ní přijel její manžel, se kterým v té době už několik měsíců nežila.
Celý článek- 13.02.2020
Na internetu nabízel stavební materiál. Škoda přes 600 tisíc
Kriminalistům z oddělení hospodářské kriminality v Chebu se díky dlouhodobé a usilovné práci podařilo odhalit muže z Prahy, který se dopouštěl své trestné činnosti nejméně tři čtvrtě roku po celém území České republiky, a to prostřednictvím internetu. Osmatřicetiletý muž v době od září roku 2012 do července 2013 v úmyslu se obohatit, měl zveřejnit inzeráty na různých inzertních internetových portálech, ve kterých nabízel k prodeji různý stavební materiál.
Celý článek- 13.02.2020
Historické krovy představí výstava v Hofu
Na zahájení vystoupí čeští zástupci projektu. Výstava začne ve čtvrtek 13. 2. v 19.30 hodin v Muzeu Vogtland.
Celý článek- 12.02.2020
Sokolov: Městská policie má kontaktní místnost na nádraží (TV Západ)
Letitá snaha města Sokolova o řešení pocitu bezpečí ve městě získala v nedávné době další díl do mozaiky opatření. Ve zrekonstruované budově nádraží mají od nynějška společnou služebnu Městští strážníci spolu s Policií ČR. K jejímu slavnostnímu předání došlo ve středu 22. ledna.
Celý článek- 12.02.2020
Region: Policie stále pátrá po Karlu Zronkovi
Policie aktualizovala svoji databázi a opětovně prosí veřejnost o pomoc, kdy sokolovští kriminalisté pátrají po hledaném 43letém muži z Rotavy, který je přibližně 175 cm vysoké štíhlé postavy, má zelené oči a krátké rovné hnědé vlasy.
Celý článek- 12.02.2020
Karlovy Vary: Město má novou smlouvu s filmovým festivalem
Novou smlouvu mezi Nadací Film-Festival Karlovy Vary a společností Film Servis Festival Karlovy Vary podepsali primátorka města Andrea Pfeffer Ferklová a prezident festivalu Jiří Bartoška v pátek 7. února. Oproti předchozímu kontraktu, jehož desetiletá platnost vypršela na konci loňského roku, je nová smlouva uzavřená na tři roky pro město výhodnější zejména po finanční stránce.
Celý článek- 12.02.2020
ČEZ eviduje škody způsobené orkánem Sabine předběžně ve výši 25 milionů
ČEZ Distribuce v souvislosti s orkánem Sabine během noci opravila všechny poruchy na vedení vysokého napětí a obnovila dodávky elektřiny všem odběratelům elektřiny.
Celý článek- 12.02.2020
Aktuálně je neprůjezdná silnice od božídarské vodárny na Zlatý kopec
Krajští silničáři upozorňují řidiče v Krušných horách, že je aktuálně neprůjezdná silnice od božídarské vodárny na Zlatý kopec. Silnicí neprojede ani vozidlo údržby silnic kvůli bezohlednému parkování turistů a lyžařů přímo na komunikaci.
Celý článek- 12.02.2020
Chebsko: Hasiči včera vyprošťovali autobus a nákladní vůz
K větru se v úterý odpoledne a večer přidalo ještě sněžení. Hasiči následně zasahovali u dvou případu zapadnutí vozidla, kdy asistovali u vyproštění. U Aše zapadl linkový autobus, 7 pasažérů bylo bez zranění evakuováno a dopravním automobilem hasičů byli cestující převezeni do Hranic.
Celý článek- 12.02.2020
Vznik jezdeckého pomníku Karla IV. podpoří karlovarští umělci
Po krátké časové pauze, kdy byla Galerie umění Karlovy Vary uzavřena z provozních důvodů, se její prostory opět otevřou ve čtvrtek 13. února veřejnosti. Přichystána je výstava s názvem „Karlovarský salon 2020.“ Kromě prezentace autorské tvorby regionálních umělců má akce ještě hlubší smysl - chce pomoci propagovat ideu a rovněž získat finanční prostředky na realizaci jezdeckého pomníku Karla IV. v Karlových Varech. Vernisáž bude zahájena v 19 hodin.
Celý článek- 12.02.2020
Boží Dar: Osobní vozidlo skončilo mimo vozovku
Na silnici 219 u Božího Daru, okres Karlovy Vary, došlo k dopravní nehodě bez zranění - havarovalo zde osobní vozidlo. Skončilo mimo komunikaci.
Celý článek- 12.02.2020
Karlovy Vary: Pozor! Nehoda se zraněním
V Karlových Varech, v ulici Na Vyhlídce, došlo k dopravní nehodě se zraněním - střet dvou vozidel. Na místě ZZS a HZS.
Celý článek- 12.02.2020
Cheb: Pracoviště registru vozidel a řidičů čekají stavební úpravy
V termínu od 17. 2. do 3. 3. 2020 bude z důvodu prováděných stavebních úprav uzavřeno pro veřejnost pracoviště registru vozidel a řidičů v budově Městského úřadu Cheb, ulice 26. dubna 4.
Celý článek- 12.02.2020
2010 – Sokolov: Prodej bývalého krytu na Vítězné se komplikuje (3971) (TV Západ)
Prodej a využití bývalého krytu, který chátrá na sokolovském sídlišti Vítězná, se komplikuje. Před časem je získala od města církev baptistů. Ti chtějí objekt včetně pozemku získat do vlastnictví ještě před realizací projektu.
Celý článek- 12.02.2020
Chebsko: Vydírali a vyhrožovali mladému muži
Chebští kriminalisté zahájili trestní stíhání dvou mužů z Chebska ve věku 28 a 32 let, které obvinili ze spáchání přečinů vydírání a porušování domovní svobody.
Celý článek- 12.02.2020
Cheb: Strážníci získali služební psy (TV Západ)
Zatímco loňský rok byl u Městské policie ve znamení náborů, letošek pak bude věnován stabilizaci a rozvoji. V současné době má policie 30 z 34 tabulkových pracovníků a náborové příspěvky pro nové strážníky a další benefity platí i nadále.
Celý článek- 12.02.2020
Karlovy Vary: Rozešla se s ním přítelkyně. Vztek si vybil na zastávce
V sobotu dopoledne při kontrole městské části Rybáře narazili strážníci na šestatřicetiletého řidiče s úředním pobytem na karlovarském magistrátu, který řídil vozidlo pod vlivem návykové látky.
Celý článek- 11.02.2020
Podhradí u Aše: Pozor! Dočasně uzavřena komunikace
Na silnici 217 - Podhradí u Aše, okres Cheb, mezi Aší a Hranicemi je dočasně uzavřena komunikace - 1) ledovka, 2) vyprošťování uvízlého autobusu. PČR a HZS na místě události.
Celý článek- 11.02.2020
Bochov: U města havarovalo vozidlo
Na silnici 6 u Bochova, okres Karlovy Vary, došlo k dopravní nehodě - havarovalo zde osobní vozidlo.
Celý článek- 11.02.2020
Region: Chystá se velké setkání k cestovnímu ruchu (TV Západ)
V Karlovarském kraji se na konci března uskuteční výroční cestovní setkání Czech Republic Travel Trade Day. Dvoudenní obchodní jednání českých podnikatelů, regionů a dalších subjektů aktivních v oblasti příjezdového cestovního ruchu s mezinárodními nákupčími prostřednictvím B2B workshopů pořádá agentura CzechTourism ve spolupráci s Destinační agenturou pro Karlovarský kraj Živý kraj za podpory Karlovarského kraje a měst Karlovy Vary a Mariánské Lázně. Nejen tato akce byla tématem aktuálního setk
Celý článek- 11.02.2020
V Karlovarském kraji končí staré televizní vysílání
Přechod na nové televizní vysílání v Karlovarském kraji čeká 12. února 2020 skoro 300 tisíc lidí. Zatímco diváků vybavených například internetovou televizí, moderním televizorem nebo moderním set-top boxem se změna nijak dramaticky nedotkne, určité komplikace hrozí lidem žijícím v bytových domech se společnou anténou.
Celý článek- 11.02.2020
Šindelová: Stržené elektrické vedení. Neprůjezdné pro nákladní vozidla
V Šindelové u domu č.p. 33 došlo vlivem živelní události (pád stromu) ke stržení el. vedení. Izolovaný kabel cca 2 m nad vozovkou - neprůjezdné pro nákladní vozidla.
Celý článek- 11.02.2020
Jednotná linka tísňového volání funguje v České republice už šestnáct let
Stovky volání denně přijali v loňském roce operátoři tísňové linky 112 v Karlových Varech. Linka 112 slouží jako jednotné evropské číslo tísňového volaní a od začátku tuto linku obsluhuje Hasičský záchranný sbor ČR. V Karlových Varech je Telefonické centrum tísňového volání 112 součástí Krajského operačního a informačního střediska HZS Karlovarského kraje. Operátoři se zde střídají nepřetržitě ve dvanáctihodinových směnách, kdy minimální stav sloužících příslušníků jsou čtyři operátoři.
Celý článek- 11.02.2020
Chodov: Hřbitov je z bezpečnostních důvodů uzavřen
Městský hřbitov zůstane i dnes pro návštěvníky uzavřen. Důvodem uzavření je mimořádná povětrnostní situace, kdy by návštěvníky mohly ohrozit polámané či nalomené větve po vichřici. Správa hřbitova předpokládá, že hřbitov bude opět přístupný ve středu 12. února.
Celý článek- 11.02.2020
Karlovy Vary: Střet dvou vozidel
V Karlových Varech, v ulici Hybešova, došlo k dopravní nehodě bez zranění - střet dvou vozidel.
Celý článek- 11.02.2020
Hazlov: Vlak narazil do stromu
Na železniční trati u Hazlova na Chebsku dnes v odpoledních hodinách narazil osobní vlak do stromu, který spadl na koleje. Ve vlaku bylo v době nehody padesát cestujících. Nehoda byla bez zranění, všichni cestující opustili vlak a došli do zastávky Hazlov. Na místě zasahovali hasiči z jednotky Správa železnic Cheb.
Celý článek- 11.02.2020
Pozor! U Květnové hoří kamion
Na silnici 13 u Květnové hoří kamion. Kamion stojí na odpočívadle u silnice - projet se dá s opatrností oběma směry.
Celý článek- 11.02.2020
Vichřice. Hasiči řešili přes tři stovky zásahů
Silný vítr zasáhl v pondělí také Karlovarský kraj. Na základě výstrahy meteorologů zasedal od nedělního večera štáb hasičů, který se připravoval na větší počet událostí, na operačním středisku a také na příjmu tísňové linky byl posílený počet příslušníků. Během pondělní noci a dne až do úterního rána provedli hasiči v kraji celkem 358 zásahů. Z tohoto počtu se jednalo o 8 dopravních nehod, 8 požárů, 2 plané poplachy, 1 únik nebezpečných látek a 2 záchrany osob a zvířat.
Celý článek- 11.02.2020
Pernink: Pozor! Čelní střet dvou nákladních vozidel
Na silnici 221 u Perninku, okres Karlovy Vary, došlo k čelnímu střetu dvou nákladních vozidel - zaklíněný řidič, probíhá vyprošťování.
Celý článek- 11.02.2020
Karlovy Vary: Osobní vozidlo narazilo do stromu padlého přes silnici
Na silnici 20 v Karlových Varech - Tašovice, došlo k dopravní nehodě - osobní vozidlo zde narazilo do stromu padlého přes silnici (strom leží přes oba pruhy), čeká se na odstranění.
Celý článek- 11.02.2020
Aš: Pokusil se okrást nezletilého chlapce. Dokonání zabránil kolemjdoucí
Kriminalisté se zabývají případem loupeže na nezletilém chlapci, ke které došlo dne 10. února 2020 kolem 14:10 hodin v Aši v ulici Kaplanka (oblast zvaná „Sklípky“). Konfliktu měl zamezit muž, který náhodně procházel ulicí Kaplanka do ulice Hlavní a dále do ulice Horova. Tento muž měl na sobě tmavé oblečení a v ruce držel bílo-modrou igelitovou tašku.
Celý článek- 11.02.2020
Sokolovsko: Řádně nevedl účetnictví. Na dani dluží téměř 200 tisíc
Sokolovští kriminalisté zahájili trestní stíhání 53letého muže ze Sokolovska, kterého obvinili ze spáchání pokračujícího přečinu zkrácení daně, poplatku a podobné povinné platby a přečinu zkreslování údajů o stavu hospodaření a jmění.
Celý článek- 11.02.2020
2010 – Cheb: Zastupitelé schválili navýšení ceny kulturního domu (3967) (TV Západ)
Dlouho očekávaný nový kulturní dům Svoboda, který má vzniknout rozšířením stávajícího uzavřeného prostoru, bude nakonec dražší, než byly původní odhady.
Celý článek- 11.02.2020
Karlovy Vary: Využili svízelné situace seniora a uzavřeli na něj několik smluv
Kriminalisté z druhého oddělení obecné kriminality v Karlových Varech zahájili trestní stíhání dvou mužů z Karlovarska ve věku 46 a 57 let, které obvinili ze spáchání přečinu podvod.
Celý článek- 11.02.2020
Region: Ukradl klisnu
Chebští kriminalisté zahájili trestní stíhání pětadvacetiletého muže z Chebu, kterého obvinili ze spáchání přečinu krádež. Obviněný muž se měl svého protiprávního jednání dopustit nejméně ve dvou případech. Prvního skutku se měl dopustit koncem listopadu minulého roku v Chebu v místním obchodním domě.
Celý článek- 11.02.2020
Silný vítr v regionu způsobil výpadky elektřiny a komplikace v dopravě
Extrémně silný vítr během nedělní noci a v pondělí 10. února měl v Karlovarském kraji za následek přerušení dodávek elektrické energie a zastavení dopravy na několika železničních tratích, kde byl provoz následně obnoven. ČEZ vyhlásil pro území regionu kalamitní stav - bez elektřiny bylo více než 2500 přípojek. Po ranním pádu stromu na osobní automobil v Aši byl jeden zraněný člověk převezen záchranáři na chirurgickou ambulanci chebské nemocnice.
Celý článek- 10.02.2020
ČEZ vyhlásil kalamitní stav nejen v našem kraji
K 16:00 hodině evidoval ČEZ dispečink 299 poruch na vedení vysokého napětí, bez elektřiny bylo na zásobovacím území ČEZ Distribuce 207 tisíc odběratelů. Nejvíce poruch se řešilo v terénu ve Středočeském kraji – 66 poruch na vn, kdy bez elektřiny bylo 39 tisíc domácností.
Celý článek- 10.02.2020
Karlovarský kraj: Zprávy 07. týdne 2020 (TV Západ)
Vysílání 10.02.2020-14.02.2020, 1. Region: Chystá se velké setkání k cestovnímu ruchu (TV Západ), 2. Cheb: Strážníci získali služební psy (TV Západ), 3. Sokolov: Městská policie má kontaktní místnost na nádraží (TV Západ), 4. Cheb: Modely vláčků přilákaly přes 3 tisícovky návštěvníků (TV Západ), 5. Sokolov: Ve městě se letos modernizuje 38 zastávek MHD (TV Západ), 6. Region: Seniorská obálka pomůže i zdravotníkům (TV Kraj)
Celý článek- 10.02.2020
Nová Ves: Tragická nehoda. Na jedoucí vozidlo spadl strom
V souvislosti se silným větrem přijali policisté na lince 158 od dnešní půlnoci do 15. hodiny odpolední na šest desítek oznámení. Nejčastěji se jednalo o popadané stromy na komunikaci. V několika případech stromy popadaly dokonce i na zaparkovaná či jedoucí osobní vozidla.
Celý článek- 10.02.2020
Jáchymov: Nové jedinečné minerály rozšířily geologickou sbírku muzea
Čtyři nové jedinečné vzorky minerálů obohatily geologickou expozici Muzea Karlovy Vary v Královské mincovně v Jáchymově, a to díky daru pana Ing. Václava Zemka z Vlašimi a dlouhodobé spolupráci s dr. Jakubem Plášilem z Fyzikálního ústavu Akademie věd.
Celý článek- 10.02.2020
Sokolov: O studium vojenské školy projevilo zájem 71 budoucích studentů
Karlovarský kraj počítá pro příští školní rok 2020/2021 s otevřením pobočky Vojenské střední školy a Vyšší odborné školy Ministerstva obrany Moravská Třebová v Sokolově.
Celý článek- 10.02.2020
Cheb: Od narození Boženy Němcové uplynulo 200 let
Nová výstavka v knihovně připomíná jednu z našich nejvýznamnějších ženských osobností - Boženu Němcovou, svobodomyslnou spisovatelku pozdního romantismu, od jejíhož narození právě uplynulo 200 let. Žila pouhých 41 let - v komplikovaném a smutném manželství, nakonec i v chudobě, přesto nepřestávala tvořit.
Celý článek- 10.02.2020
Karlovarský kraj: Počet nemocných respirační infekcí mírně klesá
Nemocnost akutních respiračních infekcí (dále jen „ARI“) v Karlovarském kraji vychází z týdenních hlášení praktických lékařů pro dospělé a praktických lékařů pro děti a dorost. Jedná se o vážená a standardizovaná data s využitím počtu obyvatel v jednotlivých okresech a jednotlivých věkových skupinách.
Celý článek- 10.02.2020
2010 – Sokolov: Protipovodňové opatření na Lobezském potoce (3969) (TV Západ)
Původní plány sokolovské radnice na ochranu města před velkou vodou se nakonec neuskuteční. Tato situace je již nějakou dobu známa a tak město připravilo nový projekt.
Celý článek- 10.02.2020
Cheb: Ve městě se nejen kácí, ale i vysazují nové stromy
Nelibost vůči kácení dřevin dává veřejnost jasně najevo především prostřednictvím sociálních sítí.
Celý článek- 10.02.2020
Sokolov: Pro ženy a seniory je opět připraven kurz sebeobrany
Zvládnout krizové situace, dozvědět se základy z trestního práva a posílit si sebevědomí. A také praktický trénink technik, při jejichž použití lze čelit napadení. To vše čeká na účastníky jarního kurzu sebeobrany pro ženy a seniory. V Sokolově začne 20. února a potrvá tři měsíce. Kurz je pro účastníky zdarma a povede ho zkušený lektor, policista Jiří Matouš, držitel 7. Danu.
Celý článek- 10.02.2020
Chebsko: Prodával marihuanu a pervitin
Chebští kriminalisté zahájili trestní stíhání dvaatřicetiletého muže z Chebu, kterého obvinili ze spáchání přečinu nedovolená výroba a jiné nakládání s omamnými a psychotropními látkami a s jedy.
Celý článek- 09.02.2020
2010 – Cheb: Bude obnoveno chebské pivo (3964) (TV Západ)
Chebskou hradní jedenáctku, pivo, které si ještě mnozí pamatují, budete mít možnost po dlouhé době opět ochutnat. Přímo na náměstí vznikne nad kavárnou Bartoloměj restaurace, kde se chebské pivo bude čepovat. Prozatím se sice bude vyrábět ve Waldsassenu, ale do budoucna by provozovatelé rádi přemístili výrobu na území města.
Celý článek- 09.02.2020
Nemocnice Ostrov obhájila titul nejoblíbenější nemocnice v Karlovarském kraji
Nemocnice Ostrov se stala opět podle hlasování pacientů nejoblíbenější nemocnicí Karlovarského kraje. Titul Nemocnice ČR 2019 obhájila na Karlovarsku již popáté za sebou. V celostátním srovnání jí patří 21. místo mezi 154 hodnocenými nemocnicemi. Bodovala i v hodnocení ambulancí, kde jí pacienti přisoudili stříbrnou pozici v kraji a 26. místo v celé ČR.
Celý článek- 09.02.2020
Chodov: Strážníci dostanou nové auto
Chodovští strážníci budou v dohledné době jezdit v novém voze. Dosluhující Škodu Yeti nahradí Kodiaq s automatickou sedmistupňovou převodovkou.
Celý článek- 09.02.2020
2000 – Cheb: První letošní miminka dostala Jednodukát z ryzího zlata (TV Západ)
Minulý víkend se v historických prostorách obřadní síně chebské radnice uskutečnilo první letošní vítání nových občánků města. Rodiče prvních čtyř letos narozených miminek převzali při této příležitosti z rukou starosty Ing. Václava Jakla Jednodukát z ryzího zlata.
Celý článek- 09.02.2020
Bochovsko: Mladistvé dívce prodal alkohol
Kriminalisté z druhého oddělení obecné kriminality v Karlových Varech zahájili trestní stíhání sedmačtyřicetiletého cizince, kterého obvinili ze spáchání přečinu podání alkoholu dítěti.
Celý článek- 09.02.2020
2000 – Cheb: Ministerstvo dopravy šetří a silničáři se obávají dopadu (TV Západ)
V únoru loňského roku zažívali chebští silničáři velmi krušnou zimu. Touto dobou již vyčerpali všechen posypový materiál a další jen stěží sháněli. Letos, zdá se, podobná situace nehrozí.
Celý článek- 08.02.2020
2000 – Cheb: Výstavbu sportovního areálu u 1. ZŠ provází komplikace (TV Západ)
Na jaře loňského roku byla zahájena výstavba víceúčelového sportovního areálu u 1. ZŠ na chebském sídlišti Skalka. Areál měl být dokončen v termínu 31. srpna loňského roku.
Celý článek- 08.02.2020
Karlovy Vary postoupily do celostátního kola soutěže o titul Historické město roku 2019
Město Karlovy Vary postoupilo do celostátního kola soutěže o titul Historické město roku 2019. Lázeňské město zvítězilo v krajském kole soutěže o Cenu za nejlepší přípravu a realizaci Programu regenerace městských památkových rezervací a městských památkových zón, kterou již od roku 1994 vyhlašuje Ministerstvo kultury ČR.
Celý článek- 08.02.2020
Získejte dotaci v soutěži Obec přátelská rodině a seniorům
Ministerstvo práce a sociálních věcí ČR ve spolupráci s partnery vyhlásilo další ročník soutěže „Obec přátelská rodině a seniorům.“ Pro vítěze jednotlivých kategorií je připraveno celkem 12 milionů korun. Zájemci mohu přihlašovat své projekty na realizaci proseniorských a prorodinných aktivit až do 29. února.
Celý článek- 08.02.2020
2000 – Region: Riskantní předjížděcí manévr stál motocyklistu život (TV Západ)
Již ke třetí dopravní nehodě, při které vyhasl lidský život, došlo od počátku roku na silnicích Chebska. K nehodě, při níž zahynul 60letý motocyklista ze sousedního německého Bayreuthu, došlo na trase z Chebu do Sokolova, kousek za odbočkou na Lipoltov. Osudným se pro motocyklistu jedoucím na motocyklu Yamaha se stal riskantní předjížděcí manévr.
Celý článek- 08.02.2020
Sokolovsko: Prodával drogy mladistvým
Kriminalisté z druhého oddělení obecné kriminality v Sokolově zahájili trestní stíhání 25letého muže ze Sokolova, kterého obvinili ze spáchání zvlášť závažného zločinu nedovolená výroba a jiné nakládání s omamnými a psychotropními látkami a s jedy.
Celý článek- 08.02.2020
2000 – Cheb: Vybudování Průmyslové zóny stále provází nejistota (TV Západ)
Chebská radnice stále nemá jistotu, zda se jí podaří zrealizovat myšlenku vybudování průmyslového parku ve vytipované lokalitě u obchvatu města. V první etapě totiž počítá s investicemi do pozemků o rozloze asi 50 hektarů, kde však má v majetku pouze pětinu půdy.
Celý článek- 07.02.2020
Karlovarský kraj: Archivní zprávy 06. týdne 2020 (TV Západ)
Vysílání 07.02.2020-10.02.2020 1. 2000 – Cheb: Vybudování Průmyslové zóny stále provází nejistota (TV Západ) 2. 2000 – Region: Riskantní předjížděcí manévr stál motocyklistu život (TV Západ) 3. 2000 – Cheb: Výstavbu sportovního areálu u 1. ZŠ provází komplikace (TV Západ) 4. 2000 – Cheb: Ministerstvo dopravy šetří a silničáři se obávají dopadu (TV Západ) 5. 2000 – Cheb: První letošní miminka dostala Jednodukát z ryzího zlata (TV Západ)
Celý článek- 07.02.2020
Region: Meteorologové varují před velmi silným větrem
Výstraha platí od 18:00 hodin dne 9.2.2020 do 18:00 hodin dne 11.2.2020, a to pro kraje: Hlavní město Praha, Středočeský kraj, Jihočeský kraj, Plzeňský kraj, Karlovarský kraj, Ústecký kraj, Liberecký kraj, Královéhradecký kraj, Pardubický kraj, Kraj Vysočina, Olomoucký kraj (Jeseník, Šumperk), Moravskoslezský kraj.
Celý článek- 07.02.2020
Kamna W. Russe budou na podzim umístěna v expozici Muzea Cheb
Kamna ze sbírky Muzea Cheb, která vytvořil v letech 1941-1944 sochař a keramik Willy Russ, jsou hodnotná svou jedinečností a řemeslným zpracováním, ale i historickou a etnografickou vypovídací hodnotou – vyobrazením a popisu lidových zvyků a přesným zachycení krojů. Od září 2019, kdy byla kamna stojící na Chebském hradě předána restaurátorskému ateliéru Sylvy Antony Čekalové, probíhá jejich postupné rozebírání a následný transfer jednotlivých částí do ateliéru.
Celý článek- 07.02.2020
Nedostatek lékařů pociťuje celé Česko. V příhraničí je však situace již kritická
Není žádným tajemstvím, že Karlovarský kraj, coby jeden ze tří strukturálně postižených regionů, trpí odchodem mladých a talentovaných lidí a jejich rodin do jiných regionů v ČR i v zahraničí. Chebsko není výjimkou. Nedostatek lékařů, učitelů, absence odborných zaměstnanců v oblasti sociálních služeb, nedostatek volných lůžek pro seniory a zdravotně postižené občany jsou témata, která v posledních letech rezonují převážně v příhraničních oblastech.
Celý článek- 07.02.2020
Běžecké stopy v Krušných horách hlásí ideální podmínky
Díky příznivým podmínkám se rolbařům podařilo v uplynulých dnech upravit desítky kilometrů běžeckých tras. Od včerejška mohou běžkaři vyrazit na Krušnohorskou magistrálu v téměř celé její délce od Božího Daru až po Bublavu. Navazují na ní napojení dalších obcí a cílů, včetně Abertam, Hřebečné, Ryžovny, Bludné, Plešivce nebo Chaloupek.
Celý článek- 07.02.2020
Cheb: Schovala se na toaletě v restauraci. Po zavíračce pak kradla
Policisté z Obvodního oddělení Cheb – město sdělili 25leté ženě z Chebska podezření ze spáchání přečinu krádež. Takového skutku se měla žena dopustit ke konci ledna v Chebu v místní restauraci. Původně jako host, se měla úmyslně zavřít na dámské toaletě a setrvat tam do konce provozní doby.
Celý článek- 07.02.2020
Sokolovsko: Povedená vnučka. Svému dědovi odcizila platební kartu
Policisté z Obvodního oddělení Horní Slavkov sdělili podezření 25leté ženě z Chebska ze spáchání přečinu neoprávněné opatření, padělání a pozměnění platebního prostředku.
Celý článek- 07.02.2020
Mariánské Lázně: Dnes ráno došlo na železniční trati k tragické nehodě
Na železniční trati u Mariánských Lázní byla dnes ráno vlakem sražena osoba. Bohužel osoba utrpěla smrtelná zranění. Ve vlaku cestovalo celkem 9 osob, které hasiči převezli dopravním automobilem na nádraží. Provoz na trati byl v 9:30 plně obnoven.
Celý článek- 07.02.2020
Karlovarsko: Vloupávali se do vozidel
Karlovarským kriminalistům se podařilo po intenzivním pátrání dopadnout dva muže ve věku 40 a 43 let, kteří se měli v lednu tohoto roku opakovaně dopouštět majetkové trestné činnosti. Muži se měli vloupat na území Karlovarska a Sokolovska do celkem pěti zaparkovaných vozidel.
Celý článek- 07.02.2020
Cheb: Významnou Cenu města získala paní Alena Kovaříková (TV Západ)
V obřadní síni Městského úřadu Cheb se v pondělí 27. ledna konalo slavnostní předání Ceny města Chebu za zásluhy o rozvoj v oblasti kultury a za příkladnou občanskou aktivitu. Cenu z rukou starosty převzala paní Alena Kovaříková, která je veřejnosti známa především svojí činností o záchranu poutního areálu Maria Loreto ve Starém Hrozňatově. Pogratulovat paní Kovaříkové přišla nejen rodina, ale také chebští zastupitelé a členové rady města, a také přátelé a známí.
Celý článek- 07.02.2020
Aš: Město chce přemístit památník Americké armády k radnici
Přesunutí monumentu a úpravy jeho okolí vyjdou dle projektové dokumentace na dva milióny korun. Dotace od státu je až 80 % uznatelných nákladů.
Celý článek- 06.02.2020
Bochov: Na plese byli oceněni tanečníci i zachránce (TV Západ)
Již 12. reprezentační ples města Bochova proběhl v sobotu 18. ledna. I letos se těšil velkému zájmu obyvatel města i okolí a přinesl pestrý program.
Celý článek- 06.02.2020
Cheb: Změna přednosti v jízdě - křižovatka Písečná x Dyleňská x U Stadionu
Po rekonstrukci ulice Písečná dojde i k nestavební úpravě křižovatky Písečná x Dyleňská x Příkopní a navazující křižovatky s ulicí U Stadionu. Úprava bude spočívat ve vymalování nového vodorovného značení s umístěním zelených sloupků (balisetů) - viz foto.
Celý článek- 06.02.2020
Experti z EU budou pomáhat v přeměně Sokolovska po dobu dvou let
Na pracovní návštěvu Karlovarského kraje přijeli zástupci Sekretariátu Platformy pro transformaci uhelných regionů a pozorovatelé z Generálního ředitelství Evropské komise. Expertní skupina se během tří dnů seznámila s historií a současnou situací Sokolovska a celého kraje, s okolnostmi plánovaného útlumu těžby aex s problematikou řešení jeho dopadů.
Celý článek- 06.02.2020
Sokolovsko: Týral svoji družku. Bil jí teleskopickým obuškem
Kriminalisté z druhého oddělení obecné kriminality v Sokolově zahájili trestní stíhání 46letého muže ze Sokolovska, kterého obvinili ze spáchání zločinu týrání osoby žijící ve společném obydlí a přečinu nebezpečné vyhrožování.
Celý článek- 06.02.2020
Sokolovsko: Nezvládl řízení a s vozidlem skončil mimo komunikaci
Sokolovští dopravní policisté pátrají po svědcích dopravní nehody, ke které došlo dne 23. ledna 2020 kolem půl sedmé hodiny večerní v katastru obce Chodov v blízkosti křižovatky se silnicí třetí třídy č. 1812.
Celý článek- 06.02.2020
Březová: Na šestce havarovalo vozidlo
Na D6 - 145 km na trase Dvory - Cheb došlo k dopravní nehodě bez zranění - havarovalo zde osobní vozidlo. Na místě PČR. Pozor! Vozidlo v pravém odstavném pruhu částečně zasahuje do komunikace.
Celý článek- 06.02.2020
Region: Mladík padělal bankovky
Kriminalisté z odboru hospodářské kriminality se v poslední době zabývali případem padělání a pozměnění peněz, kdy měl neznámý pachatel zhotovit padělky bankovek nominální hodnoty 100 korun a následně je udat v různých obchodech na Karlovarsku do oběhu jako pravé.
Celý článek- 06.02.2020
2010 – Šindelová: Rekordní mrazy v nejstudenějším místě regionu (3958) (TV Západ)
Tuhé mrazy sevřely náš region v uplynulém týdnu. Nejstudenější místo jsme navštívili s kamerou, abychom zjistili, jak působí třicetistupňový mráz. V malé osadě Šindelová, kde žije pár set stálých obyvatel, sídlí pracoviště Českého hydrometeorologického ústavu Plzeň. Měření se zde provádí od roku 1986.
Celý článek- 06.02.2020
Sokolov: Studenti coby podnikatelé představili své fiktivní firmy
Firmy, které existují jen pár dní, jejich jména jste asi nikdy neslyšeli a nic si od nich nepořídíte. Přesto musí alespoň na čas fungovat, jako by byly skutečné. Jejich šéfové a zaměstnanci, v tomto případě studenti, vymýšlí podnikatelské záměry, strategie i kampaně.
Celý článek- 06.02.2020
Karlovy Vary: Během tří dnů rozdali strážníci pokuty za 42 tisíc
Na konec ledna městská policie připravila kontrolu povolení k vjezdu do lázeňského území. Strážníci ji provedli v různých časech v rozmezí tří dnů a zkontrolovali 953 řidičů. Bez platného oprávnění k vjezdu bylo přistiženo 127. Strážníci v úhrnu udělili pokuty za 42 600 Kč.
Celý článek- 06.02.2020
Region: Vážné dopravní nehody na silnici I/6
Policisté v Karlovarském kraji upozorňují řidiče, aby na silnicích dbali zvýšené opatrnosti a přizpůsobili svojí jízdu aktuálním povětrnostním podmínkám. Letošní zimní počasí je velmi proměnlivé a je důležité myslet na to, že náledí se může nacházet i na silnici, která na první pohled nejeví známky námrazy a je černá.
Celý článek- 05.02.2020
Žákyně oboru kosmetické služby ovládly evropské finále v Bratislavě
V úterý 4. 2. 2020 se konalo ve slovenské Bratislavě **EVROPSKÉ FINÁLE soutěže KORUNA KREATIVITY** - OPEN INTERNATIONAL CHAMPIONSHIP OF EUROPE CROWN OF CREATIVITY 2020. Naše žákyně oboru KOSMETICKÉ SLUŽBY se musely do EVROPSKÉHO FINÁLE kvalifikovat a to se jim podařilo na soutěži BEAUTY CUP 2020 v Domažlicích. Tam se umístila Sarah Kotálová ze třídy 3. KOS na 1. místě a Barbora Petráčková ze třídy 4. KOS na 3. místě :-) MISTROVSTVÍ EVROPY v Bratislavě se zúčastnilo celkem 14 soutěžících.
Celý článek- 05.02.2020
Sokolov: Lidické nábřeží se dočká opravy (TV Západ)
Dlouho očekávaná rekonstrukce Lidického nábřeží v Sokolově začne nejspíše v jarních měsících letošního roku. Obyvatelé se budou muset obrnit trpělivostí, protože bude komunikace částečně ve dvou etapách uzavřená.
Celý článek- 05.02.2020
Letiště Karlovy Vary hlásí za uplynulý rok další nárůst provozu
Letiště Karlovy Vary zaznamenalo v roce 2019 nárůst provozu. Odbaveno bylo celkem 62 434 cestujících, což znamená meziroční nárůst přes 43 procenta. Letiště za to vděčí zejména spolupráci s leteckou společností Pobeda, která provozuje pravidelnou linku mezi letištěm Vnukovo v Moskvě a Karlovými Vary.
Celý článek- 05.02.2020
Chodov: Město zve na Staroměstský masopust
Tradiční Staroměstský masopust se uskuteční dne 16.2.2020 od 08:00 hodin, a to v Chodově - Staroměstská ulice.
Celý článek- 05.02.2020
Ostrov: U dnešní nehody zasahovaly všechny složky IZS
Všechny složky IZS dnes zasahovaly u dopravní nehody se zraněním u města Ostrov. Provoz byl omezen. Hasiči provedli vyproštění jedné osoby a záchranná služba služba transportovala celkem dvě zraněné osoby do zdravotnického zařízení.
Celý článek- 05.02.2020
Nová Role: Dva muži napadli ženu. Ta musela vyhledat lékaře
Policisté z Obvodního oddělení v Nové Roli sdělili 50letému muži z Karlovarska podezření ze spáchání přečinů ublížení na zdraví ve stádiu pokusu, porušování domovní svobody, nebezpečné vyhrožování a výtržnictví spáchané formou spolupachatelství. Sdělení podezření ze spáchání přečinů porušování domovní svobody a výtržnictví spáchané formou spolupachatelství si převzal i 49letý muž z Karlovarska.
Celý článek- 05.02.2020
Sadov: U obce došlo k dopravní nehodě
Na silnici 13 u Sadova, okres Karlovy Vary, došlo k dopravní nehodě - bez zranění - střet nákladního vozidla s osobním.
Celý článek- 05.02.2020
Karlovarsko: Pohřešovaná 16letá dívka
! Aktualizace 5.2.2020 - 13:45 - dívka se našla, moc všem děkujeme za sdílení ! Byli jsme požádáni o pomoc při pátrání po 16leté Nikole Habartové. Pokud jste pohřešovanou viděli, obraťte se na nejbližší policejní služebnu, volejte linku 158 či tel. č. 725 391 561.
Celý článek- 05.02.2020
2010 – Cheb: Lupiči si odnesli z kasina milion korun (3962) (TV Západ)
Dvojice maskovaných lupičů si odnesla minulý týden v ranních hodinách z chebského kasina v areálu Dragoun milion korun. Pachatelům se podařilo překvapit končící noční směnu těsně před zavírací dobou. V té chvíli byly v areálu ostatní provozovny a obchody ještě zavřené.
Celý článek- 05.02.2020
Karlovy Vary: V knihovně se bude konat Den zdravého mozku a paměti
Odborná konference s názvem „Den zdravého mozku a paměti – vliv moderních technologií“ se bude konat v prostorách Krajské knihovny Karlovy Vary 19. 3. 2020.
Celý článek- 05.02.2020
Sokolovsko: Prodával pervitin
Kriminalisté z druhého oddělení obecné kriminality v Sokolově zahájili trestní stíhání dvaatřicetiletého muže ze Sokolovska, kterého obvinili ze spáchání přečinu nedovolená výroba a jiné nakládání s omamnými a psychotropními látkami a s jedy.
Celý článek- 05.02.2020
Cheb: Nedostatek praktických lékařů je kritický (TV Západ)
Kritický nedostatek praktických lékařů zažívá město Cheb a jeho obyvatelé. Před nedávnem skončil MUDr. Kárník v Hradební ulici, praxi ukončí podle dostupných informací také dr. Rajzl s ordinací v Písečné ulici. Město Cheb samo má jen omezené možnosti jak situaci řešit. Iniciovalo proto mimo jiné jednání s ostatními lékaři.
Celý článek- 05.02.2020
Bochov: Při včerejší vážné nehodě se zranilo pět osob
Na silnici I/6 u Bochova včera u vážné dopravní nehody opět zasahovaly všechny složky IZS.
Celý článek- 04.02.2020
Ostrov: Veřejnosprávní obor na SPŠ zůstane (TV Západ)
Po návštěvě ředitele ostrovské Střední průmyslové školy revokovala Rada Karlovarského kraje své rozhodnutí o uzavření studijního oboru Veřejnosprávní činnost. Pro tuto změnu bylo hned několik argumentů.
Celý článek- 04.02.2020
Region: Silný vítr vyvracel stromy
V noci z pondělí na úterý silný vítr vyvracel stromy i v Karlovarském kraji. Kmeny popadané na komunikace museli odstraňovat hasiči.
Celý článek- 04.02.2020
Česká televize dnes o půlnoci vypíná další DVB-T vysílače
V Plzeňském kraji bude dnes vypnut vysílač Plzeň - Krašov a Domažlice - Vraní vrh a od 26.2.2020 pak Sušice - Svatabor.
Celý článek- 04.02.2020
Luby: Hasiči likvidovali požár domu
Sbor dobrovolných hasičů Skalná dnes likvidoval v ulici Západní v Lubech požár domu.
Celý článek- 04.02.2020
Bochov: Střet osobního vozidla s nákladním
Na silnici 6 u Bochova, okres Karlovy Vary, směr Praha, došlo k dopravní nehodě se zraněním - střet osobního vozidla s nákladním. Vozovka je uzavřena v obou směrech. Na místě zasahují všechny složky IZS. Objízdná trasa vede přes Bochov - Toužim - Žlutice.
Celý článek- 04.02.2020
Sedlec: Pozvánka na vzpomínkový Anjusfest
V Sedlecké pivnici v karlovarské městské části Sedlec se uskuteční v sobotu 8. února od 19 hodin III. ročník festivalu Anjusfest.
Celý článek- 04.02.2020
Karlovarsko: Odcizil stovku losů. Výhru si nechal vyplatit
Policisté z Obvodního oddělení Teplá ve spolupráci s chebskými kriminalisty dopadli osmadvacetiletého muže, který se měl na začátku ledna letošního roku dopustit krádeže v malé obci na Karlovarsku. V dopoledních hodinách se měl nejprve za pomocí přinesených nástrojů vloupat do hospody a odcizit odtud téměř stovku stíracích losů.
Celý článek- 04.02.2020
Karlovy Vary, Doubí: Pozor! Nehoda. Na místo jede PČR
V ulici Studentská v Karlových Varech, Doubí, došlo k dopravní nehodě bez zranění. Na místo jede PČR. Pozor! Překážka na vozovce. Průjezd je možný se zvýšenou opatrností.
Celý článek- 04.02.2020
Aš: Pod vlivem alkoholu ujížděl policistům
Koncem ledna tohoto roku si v pozdních večerních hodinách policisté z Obvodního oddělení v Aši během dohledu nad bezpečností a plynulostí silničního provozu všimli podezřelé jízdy osobního automobilu značky Škoda. Policejní hlídka se proto vozidlo rozhodla předepsaným způsobem zastavit. Na pokyny k zastavení však řidič nereagoval.
Celý článek- 04.02.2020
2010 – Cheb: Bývalý supermarket chce převzít nový provozovatel (3960) (TV Západ)
Jediný supermarket na chebském sídlišti Skalka je již od loňského června uzavřen. V místě žije zhruba pět tisíc obyvatel, kterým k nákupům zbývají dvě malé prodejny a večerka nebo supermarkety ve městě.
Celý článek- 04.02.2020
Sokolov: V lesoparku Hard pokračuje další část regenerace území
Další část regenerace území letos pokračuje v lesoparku mezi rozhlednou Hard a ulicí Heyrovského. Revitalizací dlouhodobě neudržovaného území bez výrazných pěstebních zásahů dojde ke zvelebení celé lokality. Akce s oficiálním názvem Regenerace lesoparku pod rozhlednou Hard – 2. etapa začala vloni na podzim a bude pokračovat do konce května 2020.
Celý článek- 04.02.2020
Karlovy Vary: Vozíčkáři se vybil akumulátor. Pomohli mu strážníci
Poslední den v měsíci lednu se nesl v duchu asistence a pomoci uniformovaných strážců pořádku občanům. Od 5 do 13 hodin vyjížděli čtyřikrát na žádost o pomoc. Ve dvou případech se jednalo o žádost seniorek, jimž upadl doma manžel, a ony jej potřebovaly uložit zpět do postele.
Celý článek- 04.02.2020
Kynšperk nad Ohří: Cihlou poničil vchodové dveře
Policisté z Obvodního oddělení Kynšperk nad Ohří sdělili podezření 27letému místnímu muži ze spáchání přečinů výtržnictví a poškození cizí věci.
Celý článek- 04.02.2020
Sokolovská nemocnice také vydala zákaz návštěv
"Dovolujeme si Vás informovat, že z důvodu zvýšeného počtu respiračních onemocnění je od 3.2.2020 v Nemocnici Sokolov vyhlášen zákaz návštěv na všech lůžkových odděleních, a to do odvolání. Předem děkujeme za pochopení," uvádí na svých facebookových stránkách Nemocnice Sokolov.
Celý článek- 03.02.2020
Karlovarský kraj: Zprávy 06. týdne 2020 (TV Západ)
Vysílání 03.02.2020-07.02.2020, 1. Ostrov: Veřejnosprávní obor na škole zůstane (TV Západ), 2. Cheb: Nedostatek praktických lékařů je kritický (TV Západ), 3. Sokolov: Lidické nábřeží se dočká opravy (TV Západ), 4. Bochov: Na plese byli oceněni tanečníci i zachránce (TV Západ), 5. Cheb: Významnou Cena města získala paní Alena Kovaříková (TV Západ), 6. Region: Zimní hry skončily (TV Kraj)
Celý článek- 03.02.2020
Sokolov: Malá Agátka učí školáky sociálnímu cítění
Výjimečný projekt, který funguje jako prevence šikany, začal na Základní škole Rokycanova v Sokolově. Je inspirován obdobným projektem z Kanady s názvem Kořeny empatie a spočívá v přítomnosti kojence ve třídě při výuce. V tomto případě je to malá Agátka a do školy s ní pravidelně přichází její maminka nebo babička.
Celý článek- 03.02.2020
Kraj chystá opravu dalších dvou domovů pro seniory
Další dva domovy pro seniory, které spravuje Karlovarský kraj, se dočkají modernizace. Rada Karlovarského kraje na svém posledním zasedání odsouhlasila realizaci zadávacího řízení na zateplení Domova pro seniory "Spáleniště" v Chebu.
Celý článek- 03.02.2020
Sokolov: Nemocnice obdržela vybavení za milion korun
Více než jeden milion korun stálo přístrojové vybavení a různé pomůcky, které sokolovská nemocnice pořídila díky daru Města Sokolov. To přispívá na koupi lékařských přístrojů na základě uzavřené dohody, kterou plní každý rok.
Celý článek- 03.02.2020
Chodov: Člověk v tísni. Projekt ve městě končí, služby ale pokračují dále
V lednu uzavřela v Chodově organizace Člověk v tísni, pobočka pro Karlovarský kraj, jeden ze svých projektů zaměřený na lidi sociálně vyloučené či sociálním vyloučením ohrožené. Pracovníci Člověka v tísni během tří let trvání projektu identifikovali několik základních problémů, které se dané lokality týkají.
Celý článek- 03.02.2020
Karlovy Vary: Dostal smyk a narazil do dvou zaparkovaných vozidel
Dopravní policisté z Karlových Varů pátrají po svědcích dopravní nehody, ke které došlo v době od 23. ledna od 18:00 hodin do 24. ledna 2020 do 9:00 hodin na ulici Svobodova v Karlových Varech na odstavném parkovišti u domu č. p. 701.
Celý článek- 03.02.2020
Karlovy Vary: Pozor! Nehoda se zraněním
Na silnici 6 u Karlových Varů (Golfák), došlo k dopravní nehodě se zraněním - střet dvou vozidel. Na místě ZZS a PČR.
Celý článek- 03.02.2020
Cheb, Karlovy Vary: Zákaz návštěv v nemocnicích
Z důvodu nárůstu počtu akutních respiračních onemocnění vyhlašuje KKN a.s. s platností od pondělí 3. února od 12:00 hodin zákaz návštěv na všech lůžkových odděleních nemocnic v Karlových Varech i v Chebu. Zákaz platí do odvolání.
Celý článek- 03.02.2020
Karlovarsko: Muži za vydírání hrozí až čtyřletý trest
Karlovarští kriminalisté zahájili trestní stíhání místního šestadvacetiletého muže, kterého obvinili ze spáchání přečinu vydírání.
Celý článek- 03.02.2020
2010 – Sokolov: Sběrné dvory vzniknou na čtyřech místech (3961) (TV Západ)
Čtyři mobilní sběrné dvory vzniknou brzy na území města Sokolova. Projekt počítá pro letošní rok s náklady ve výši 800 tisíc korun. Na každém ze čtyř míst budou k dispozici tři kontejnery na objemný a směsný komunální odpad, suť, elektroodpad nebo třeba pneumatiky.
Celý článek- 03.02.2020
Neměly by chybět v šatníku žádného muže - nejmódnější pánské kalhoty
Nemusíte být zrovna módním guru, ale váš šatník by měl obsahovat (a snad i obsahuje) alespoň několik odlišných typů kalhot. Vedle nestárnoucí klasiky ve formě džínů totiž dnes muži mají na výběr z neuvěřitelného množství kalhot pro každou příležitost i vkus. A jaké patří mezi ty neoblíbenější?
Celý článek- 03.02.2020
Region: Pro dobrovolné hasiče má kraj připraveno 11,4 milionu
Tušíte, co je proudnice, rozdělovač a savice? Pokud ano, zřejmě máte v blízkém okolí hasiče, ať už dobrovolného nebo profesionála. Hasiči pomáhají v boji s ohněm při záchraně životů, ale věnují se také hasičskému výcviku dětí a spolupráci na společenských akcích.
Celý článek- 03.02.2020
Sokolovsko: Při hádce s přítelkyní vytáhl plynovou střelnou zbraň
V polovině ledna letošního roku měl ve večerních hodinách přijet šestatřicetiletý muž společně se svou jednatřicetiletou přítelkyní k jejímu zaměstnání v jedné menší obci na Sokolovsku.
Celý článek- 03.02.2020
Jak na kamerové systémy ve školách v souvislosti s GDPR, ukázal seminář
Ve čtvrtek 23. ledna se v zastupitelském sále na krajském úřadě konal odborný seminář na téma „Bezpečná škola, kamerový systém a GDPR.“ Akci pořádal odbor bezpečnosti a krizového řízení ve spolupráci s Ministerstvem vnitra ČR a Asociací bezpečná škola.
Celý článek- 03.02.2020
Sokolov: Hasiči včera jeli k požáru domu
K ohlášenému požáru rodinného domu v Sokolově vyslalo včera operační středisko dvě jednotky HZS a dvě jednotky dobrovolných hasičů. Jednalo se o požár menšího rozsahu na verandě domu. Požár byl zlikvidován do 30 minut.
Celý článek- 02.02.2020
2010 – Cheb: Mlýnská věž na hradě je opravena (3959) (TV Západ)
Mlýnská věž na chebském hradě je opravena. Ve středověku byla součástí historického opevnění města a hradu. Věž bývala obydlena až do 30. let minulého století. Má podkovitý tvar a je dostupná z Chebského hradu.
Celý článek- 02.02.2020
SVS loni vybrala na pokutách rekordních více než 33 milionů
Státní veterinární správa (SVS) loni vybrala na pokutách více než 33 milionů korun, což bylo takřka o sedm milionů Kč více než v roce 2018. Jednalo se o nejvyšší částku v historii.
Celý článek- 02.02.2020
Region: Počet nemocných respirační infekcí a chřipkou roste
Nemocnost akutních respiračních infekcí (dále jen „ARI“) v Karlovarském kraji vychází z týdenních hlášení praktických lékařů pro dospělé a praktických lékařů pro děti a dorost. Jedná se o vážená a standardizovaná data s využitím počtu obyvatel v jednotlivých okresech a jednotlivých věkových skupinách.
Celý článek- 02.02.2020
Svatava: Hasiči likvidovali požár lokomotivy
V sobotu, hodinu před půlnocí, byl na operační středisko HZS nahlášen požár lokomotivy na železniční trati u Svatavy. Na místo byly vyslány jednotky HZS stanice Sokolov, Cheb a Hasičská záchranná služba Správy železnic z Chebu. Požár dostali hasiči během hodiny pod kontrolu.
Celý článek- 02.02.2020
2000 – Cheb: Město nemá peníze na opravu chátrající budovy muzea (TV Západ)
Chebští zastupitelé na svém posledním zasedání rozhodovali o dalším osudu městské budovy na rohu náměstí, kterou má v současné době pronajaté muzeum. Tento dům již 10 let chátrá a jeho interiéry jsou v současné době značně zdevastované. Muzeum nemůže rekonstrukci financovat, jelikož ze zákona nesmí jako státní organizace investovat do obecního majetku.
Celý článek- 02.02.2020
Sokolovsko: Starší muž kontaktoval a poté i vyhrožoval nezletilému chlapci
Sokolovští kriminalisté zahájili trestní stíhání třiapadesátiletého muže z Kladna, kterého obvinili ze spáchání přečinů navazování nedovolených kontaktů s dítětem a nebezpečného vyhrožování.
Celý článek- 02.02.2020
Nové Sedlo: Neoprávněně vstoupil do bytu. Po seniorech požadoval peníze
Policisté z Obvodního oddělení Loket sdělili podezření ze spáchání přečinu porušování domovní svobody devětatřicetiletému muži z Karlových Varů.
Celý článek- 02.02.2020
2000 – Cheb: V základních školách proběhly zápisy prvňáčků (TV Západ)
V minulém týdnu se na všech chebských základních školách uskutečnily zápisy budoucích prvňáčků. Děti se při zápisu alespoň krátce seznámí s tím, co je vlastně v prvním ročníku školy čeká.
Celý článek- 01.02.2020
Vlkovice: Při dnešní tragické nehodě vyhasly dva mladé životy
K vážné dopravní nehodě došlo dnes 1.2.2020 v brzkých ranních hodinách na pozemní komunikaci II/230 ve směru z obce Zádub – Závišín na Mariánské Lázně. K dopravní nehodě mělo dojít tak, že třiadvacetiletý řidič osobního vozidla značky BMW zřejmě vlivem vysoké rychlosti přejel do protisměru, následně vjel mimo silnici a narazil do betonového pilíře viaduktu vedoucího do obce Vlkovice.
Celý článek- 01.02.2020
2000 – Františkovy Lázně: Loupit měl chebský strážník MP (TV Západ)
Před františkolázeňskou restaurací Pod Lipou se před nedávnem odehrál konflikt, který by bylo za trochu jiných okolností možné označit za běžnou hospodskou potyčku. Tento ale vyústil v obvinění ze spáchání trestného činu. Další zajímavostí je fakt, že jedním z jeho aktérů byl strážník městské policie.
Celý článek- 01.02.2020
Region: V loňském roce bylo zjištěno téměř 6 tisíc trestných činů a přes 44 tisíc přestupků
Vyhodnocení kriminality v Karlovarském kraji za rok 2019. V roce 2019 bylo na území Karlovarského kraje zjištěno 5 735 trestných činů a 44 320 přestupků. Policisté zajistili a zadrželi 1 845 osob, 195 osob předvedli, 95 osob zatkli na základě příkazu justičních orgánů, vypátrali 78 pohřešovaných osob a 122 odcizených motorových vozidel.
Celý článek- 01.02.2020
Galerie zve na výstavu Vary v Sokolově
Galerie umění Karlovy Vary, příspěvková organizace Karlovarského kraje, zve v pondělí 3. února 2020 na zahájení výstavy: Vary v Sokolově.
Celý článek- 01.02.2020
2000 – Cheb: Střet dvou vozidel skončil smrtí mladého muže (TV Západ)
Smrtí 31letého řidiče Peugeotu 205 skončila nehoda dvou osobních automobilů v Chebu na křižovatce ulic Evropská a Pivovarská. Vůz mladého muže se při ní střetl se Škodou Octavie.
Celý článek- 01.02.2020
Habartov: Hasiči byli vysláni k otevření bytu. Osobě již bohužel nebylo pomoci
Jednotce Sboru dobrovolných Hasičů města Habartov byl dne 30.1.2020 vyhlášen poplach na technickou pomoc - otevření bytu v Habartově, v ulici Okružní. Po příjezdu jednotky na místo události zde již byla PČR Habartov, která hasiče informovala, že v kuchyni leží na podlaze osoba.
Celý článek- 01.02.2020
2000 – Cheb: Chystá se veřejná soutěž na pronájem areálu Dragoun (TV Západ)
Přestože společnostem OK LION a Euraba vyprší pronájem areálu bývalých kasáren Dragoun až letos v prosinci, radnice se dosud nevyjádřila, jaké má s areálem další úmysly. Na městský úřad přicházejí již první nabídky na jeho další využití.
Celý článek